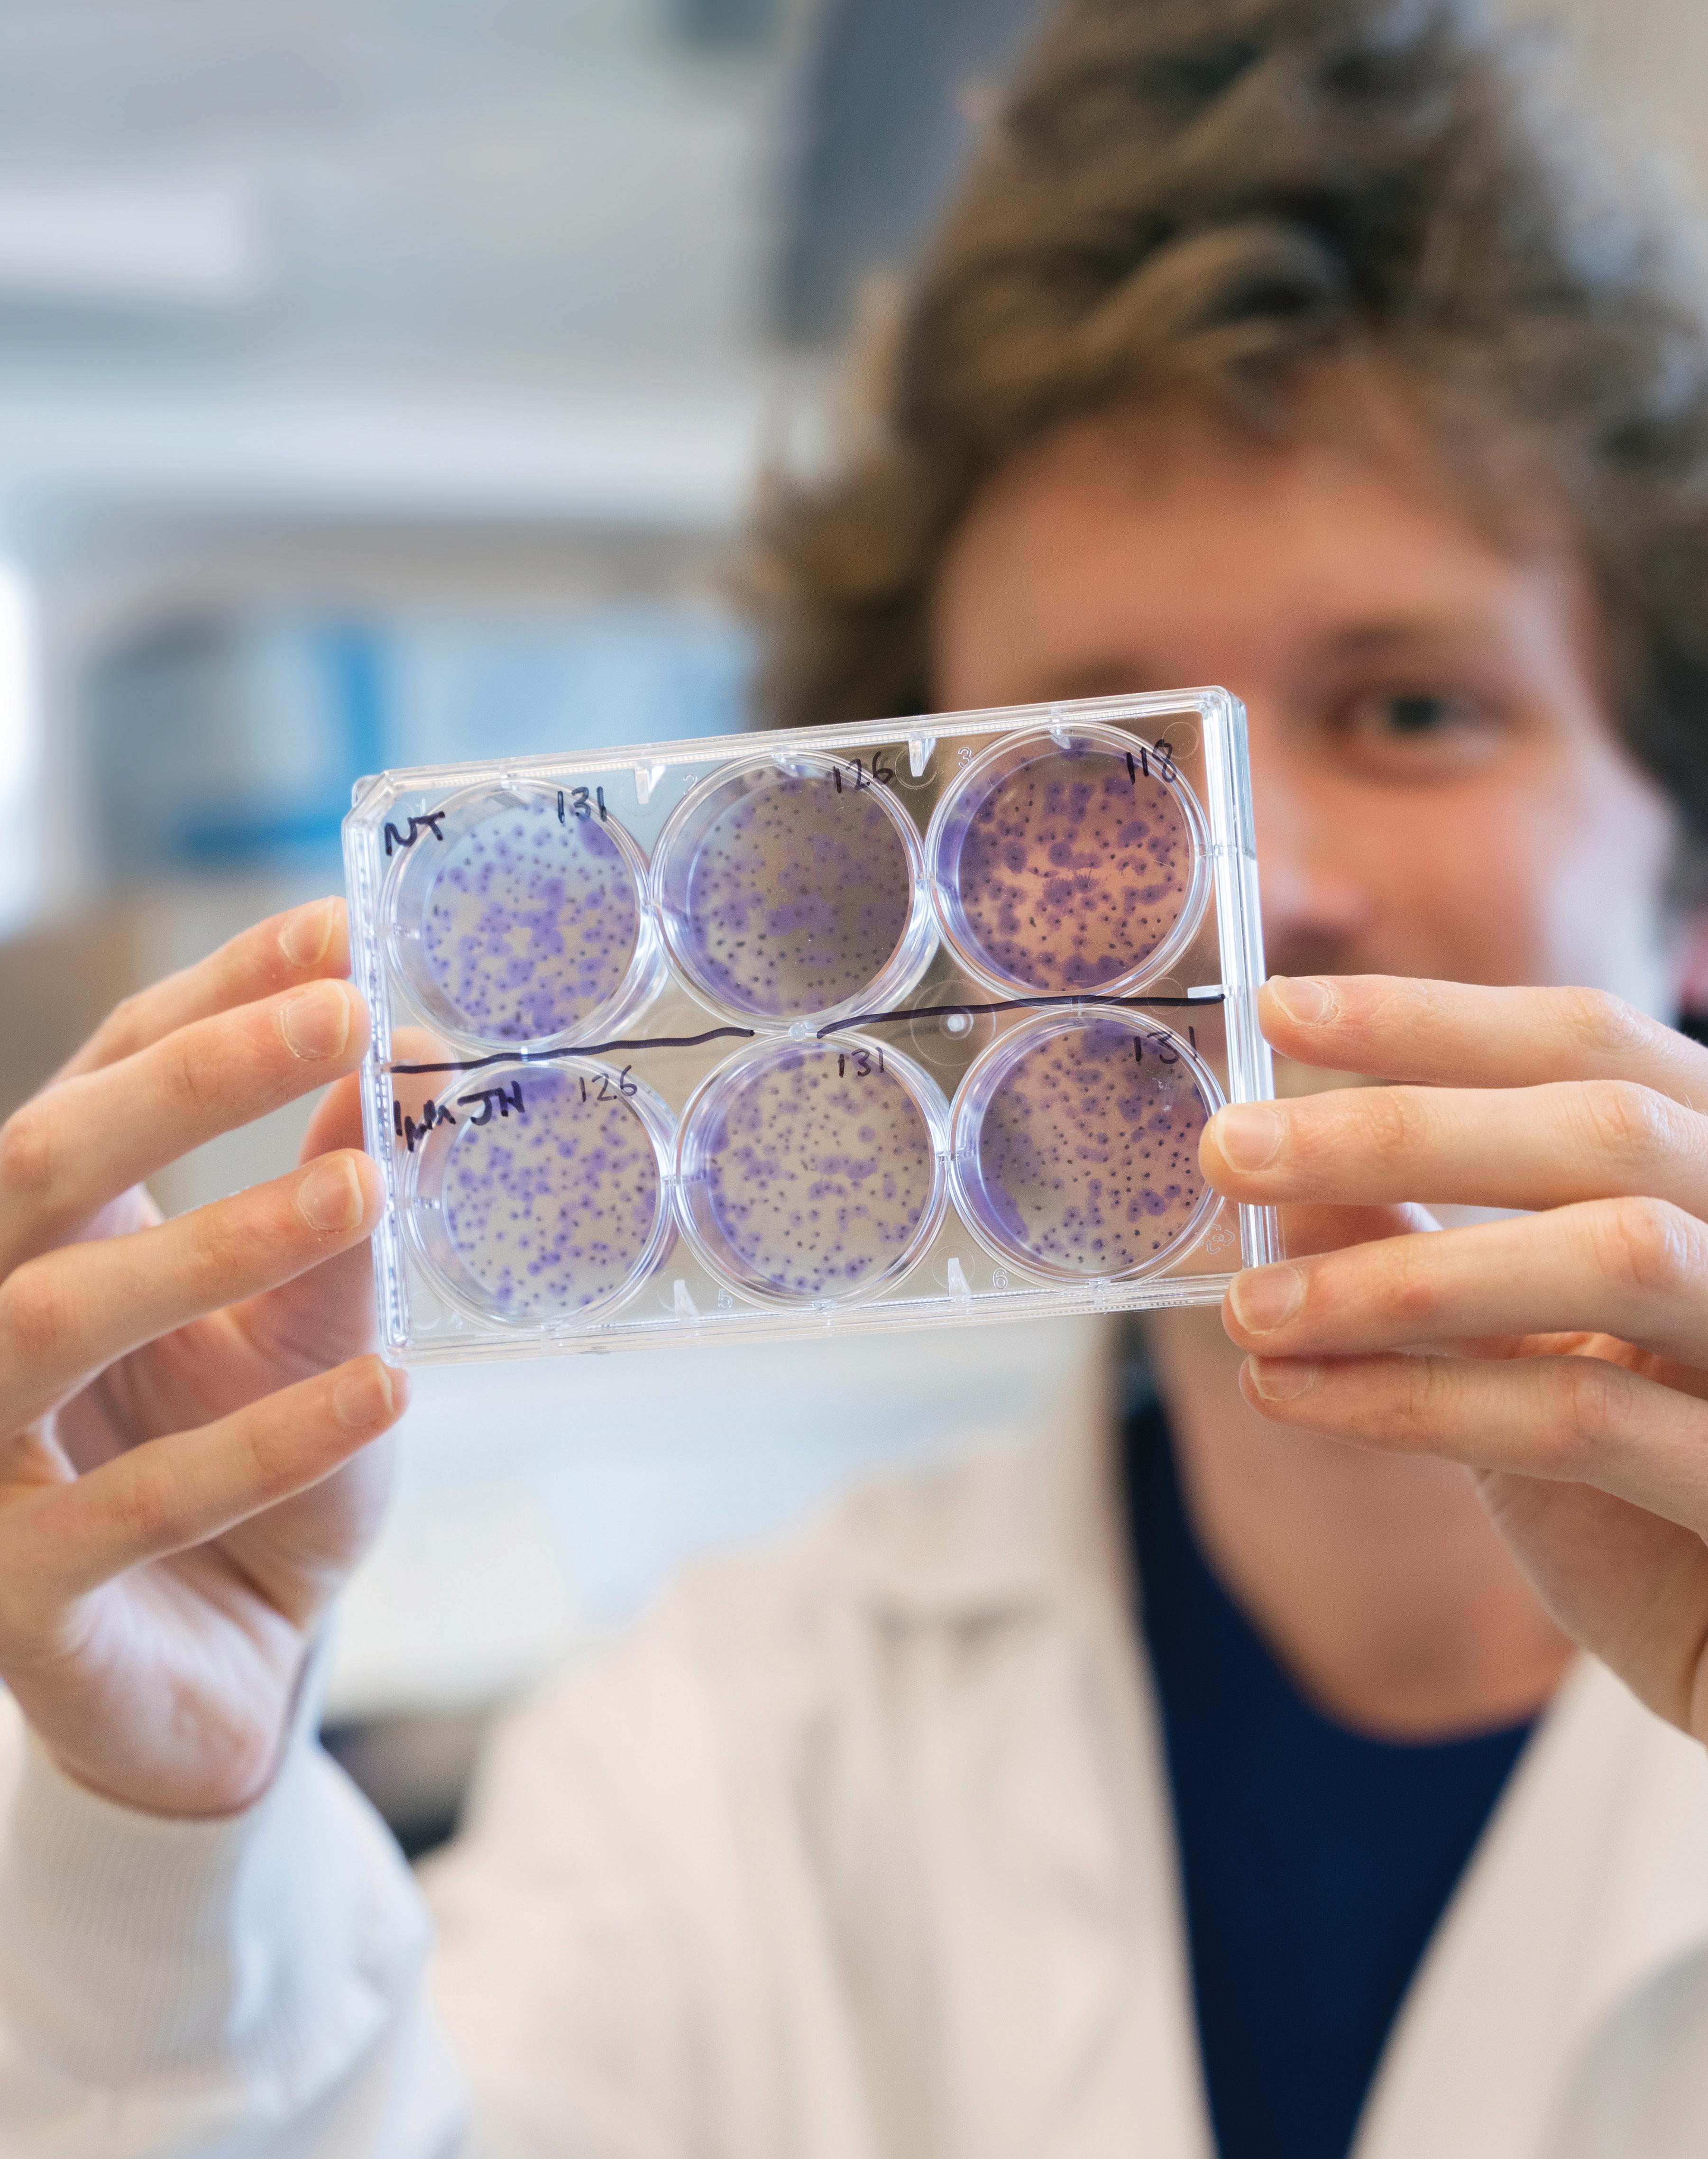

sky's the limit
UVM students soar into the future with local high-tech internships.

FALL 2022 A YEAR FOR THE AGES • INVESTING IN FUTURES • TWO CENTURIES OF SERVICE
JEFF WAKEFIELD
BY KEVIN COBURN
INVESTING IN FUTURES
 SARA WHITE
SARA WHITE
TWO CENTURIES OF SERVICE
EDWARD NEUERT
DEPARTMENTS 2 President's Perspective 6 The Green 14 Awards & Recognition 16 Research Amplified 18 UVM People: Elliot Ruggles, LICSW, Ph.D. Sexual Violence Prevention and Education Coordinator 47 Class Notes 64 Extra Credit FEATURES 20 READY FOR TAKE OFF UVM students and alumni extend their classroom learning at a Burlington aviation startup, changing the industry and what it means to be an intern. | BY
28 A YEAR FOR THE AGES Vermont Catamounts left it all on the field, on the court, on the ice, in the pool, and on the track in an historic year. |
36
For a go-getter like Lily Merchant ’24, the Grossman School of Business provides high-yield interest for her all-in approach. | BY
40
Continuing its history of academic excellence, the Larner College of Medicine celebrates its 200th anniversary in 2022. | BY
MAGAZINE UVM FRONT COVER: From the hangar to the runway—Bella Rieley ’23, Shannon Murphy ’22, and Vincent Moeykens ’21 (left to right) walk towards the Burlington International Airport runway from the Beta Technologies hangar where they are involved in shaping the future of flight. Cover Photo by Bailey Beltramo
Roughly 3,000 fresh-faced, first-time, first-year students hold up candles as they recite the UVM pledge during this year's Twilight Induction—an annual tradition on the Green that serves as the official welcome of the incoming class to UVM.
 Photo by Glenn Russell
Photo by Glenn Russell
FALL 2022
Teach students to argue. Our democracy depends on it.
UVM’s faculty and staff are always con sidering new ways to ensure student suc cess—the theme of this edition of the magazine and one of the university’s three strategic imperatives.
Most agree that graduating in a timely manner, securing gainful employment, or pursuing graduate education are evidence of success.
But there are other critical elements. One of those is making sure students learn to engage others on important topics, thorny topics, controversial topics.
If you believe, as I do, that part of a uni versity’s mission is to empower future generations to steward our democracy, our country is doing a poor job in this area. Indeed, the failure to find common ground visible in national news is mirrored—some times fostered—on college campuses.
These bleak implications for the future led Honors College Dean David Jenemann and me to try an experiment. What if we provided students an opportunity to talk with leaders and “real world” experts about polarizing societal challenges in a spirit of honesty, creativity, curiosity, and civility?
We launched a class last semester that challenged our students to understand and incorporate multiple points of view to for mulate workable solutions to current topics of national debate.
Evoking F. Scott Fitzgerald, we tested our students’ “first-rate intelligence” by asking them “to hold two opposing ideas in mind at the same time and still retain the ability to function.”
The students passed with flying colors! They engaged with one another energeti cally and openly, willing to consider other points of view, to be proven wrong, and to revise their beliefs in unexpected ways.
In fact, multiple students urged us to “bring it on!” when proposing future top ics. Some felt that more controversy and
disagreement would let them exercise more of their new capabilities—constructive, civil dialogue aimed at making the world a better place.
We had a few surprises along the way. The first—a pleasant one—was their sizable appetite for tough conversations. When we put out the call to fill our ros ter of 12 we found 150 students eager to join.
And while enthusiasm exceeded our expectations, a less-welcome surprise was that they generally knew much less than we expected about issues of contemporary importance like the environment, individ ual rights, and impact of social media—even when they were highly passionate about such topics. In fact, in each of our sessions some students confessed they didn’t know much about topics on which they held very strong opinions.
This realization led to another surprise: our students’ request for more discussion and argument in all their classes.
About midway through the semester, one student asked, “Why haven’t we had to learn this stuff? Why isn’t there a required course where we talk about issues and learn their historical contexts and complexities?”
Simultaneously, we responded, “You mean, like a civics class?”
It was clear the instant we said “civics” that our students had no idea what these two middle-aged guys were talking about.
Which leads us to our biggest takeaway: It doesn’t take much beyond a room, some guidance, and maybe a sandwich to get stu dents to reconsider some firmly held posi tions, listen to one another, and engage in constructive dialogue.
By semester’s end, our students were really good at arguing, pushing us just as we had pushed them. They told us about their private chat group where they continued
their conversations after class—without including the two of us, of course.
That’s as it should be. We’re in the busi ness of preparing young people to succeed us and exceed us after we’re gone.
In short, we must provide students practice and training in democracy, just as we expect them to master other import ant skills. Public universities like UVM are uniquely situated to accomplish this goal. I believe it’s in our mandate to do so for the public good.
While our small experiment by itself isn’t going to change the quality of national debate, imagine the impact if every student learned and practiced civil discourse the way they study writing or math—talking to people from different backgrounds about challenging subjects like guns, reproductive rights, or systemic racial inequities before stepping out into the world to do it for real.
Our class was well worth the effort –effort we’d love to see our colleagues else where make. We will continue to do our small part and challenge others to do the same.
Student success depends on it. Our democracy depends on it.
Suresh V. Garimella
President, University of Vermont

2 | UVM MAGAZINE | PRESIDENT’S PERSPECTIVE
ANDY DUBACK | PRESIDENT’S PERSPECTIVE
PUBLISHER
The University of Vermont
Suresh V. Garimella, President
EDITORIAL BOARD
Joel R. Seligman,
Chief Communications and Marketing Officer, chair
Krista Balogh, Joshua Brown, Ed Neuert, Rebecca Stazi, Barbara Walls, Benjamin Yousey-Hindes
EDITOR Barbara Walls
ART DIRECTOR
Cody Silfies
CLASS NOTES EDITOR
Benjamin Yousey-Hindes
CONTRIBUTING WRITERS
Joshua Brown, Kevin Coburn, Enrique Corredera, Christina Davenport, Joshua Defibaugh, Tucker Houston, Cheryl Herrick, Alayna Howard, Ed Neuert, Geeda Searfoorce, Jeff Wakefield, Basil Waugh, Sara White
PHOTOGRAPHY
Bailey Beltramo, Joshua Brown, Andy Duback, Isora Lithgow, Sally McCay, Glenn Russell, Ian Thomas Jansen-Lonnquist, Willy Somma
PROOFREADER Maria Landry
CORRESPONDENCE
Editor, UVM Magazine
617 Main Street
Burlington, VT 05405 (802) 656-2005, magazine@uvm.edu
ADDRESS CHANGES
UVM Foundation

411 Main Street
Burlington, VT 05401 (802) 656-9662, alumni@uvm.edu
CLASS NOTES
alumni.uvm.edu/classnotes
UVM

Thank you for investing in their journey. www.uvmfoundation.org Students find their true calling at UVM, with your support. Farmers and physicians, teachers and leaders... nurses and foresters, business owners and artists, scientists and skiers,
MAGAZINE Issue No. 91, November 2022 Publishes May 1, November 1 Printed in Vermont UVM MAGAZINE ONLINE uvm.edu/uvmmag UVM MAGAZINE twitter.com/uvmvermont instagram.com/universityofvermont facebook.com/universityofvermont youtube.com/universityofvermont FALL 2022 | 3

BAILEY BELTRAMO
2022 Commencement speaker Erik Weihenmayer P’22, (center) exits the Green accompanied by Provost Patricia Prelock (left) and Senior Coordinator, Presidential Events, Kelly O’Malley (right).
Use the
camera
on your phone or
tablet
to
scan this
QR code,
or visit
go.uvm.edu/speech22 to watch Weihenmayer's memorable speech.
YOU SHOULD KNOW
UVM TAPS NEW GENERAL COUNSEL

20 26
TOP OF THE CLASS (OF 2026)
The 3,000 first-time, first-year students making up the Class of 2026 arrived on campus better prepared than any class before them, with an average SAT score of 1,345, an average ACT score of 31, and an average GPA of 3.8. These figures each set all-time records. Read more: go.uvm.edu/2026
UVM RANKED IN TOP 100 PUBLIC RESEARCH INSTITUTIONS
UVM currently ranks 85th in the nation among 415 public research universities according to the National Science Foundation (NSF)—an indicator of the university’s commitment to expand its research portfolio in recent years.
Read more: go.uvm.edu/top100research
UPSKILL, UPSKILL, AND AWAY
519 Vermonters participated in the 2022 Upskill Vermont Scholarship program, taking up to two free professional development courses at UVM. Funded by the state for a second year, the program provides real-world training for Vermonters looking to enhance their current work skills or pivot to a new career.
In August, Trenten Klingerman joined UVM as the university’s top lawyer. As vice president for legal affairs and general counsel, Klingerman will provide legal counsel and strategy to the administration and lead the Office of the General Counsel. For the past ten years, Klingerman held leadership roles at Purdue University, where he served as deputy general counsel and chief privacy officer. Klingerman brings extensive legal experience to UVM, including ten years at a top Indiana law firm where he represented higher education institutions and other interests in court. Klingerman holds a bachelor’s degree from Purdue and a J.D. from Indiana University.
Read more: go.uvm.edu/klingerman
SAFETY FIRST
In June, former Vermont commissioner of public safety, Michael Schirling, joined UVM as the University’s Chief Safety and Compliance Officer. Schirling will lead UVM’s multi-disciplinary Safety and Compliance Division which includes Police Services, Emergency Management, Risk Management and Safety, Compliance and Privacy Services, and the University’s CatCard ID systems; all tasked with protecting the health, safety, and operational resilience of the UVM community. Schirling’s appointment follows this summer’s retirement of Vice President for Operations and Public Safety Gary Derr after 22 years of service. Read more at go.uvm.edu/schirling

OLD SCHOOL IS THE NEW SCHOOL WITH SCHOOL OF THE ARTS
Construction isn’t just happening on University Drive; the College of Arts and Sciences is building new things as well. Case in point: The new School of the Arts is a unique, collaborative arts community that brings Music, Theatre, Dance, Art, Art History, Creative Writing, and Film and Television Studies together for the first time and boasts affiliations with both The Lane Series and the Fleming Museum of Art. The result? A single creative hub led by world-class faculty dedicated to nurturing the artistic voices of the future—and encouraging collaboration with community arts organizations across Vermont. The School of the Arts made its public debut in a campus celebration in front of the Royall Tyler Theatre on October 3. Learn more: go.uvm.edu/schoolofthearts

“
I wish you a life rich with adversity, adversity that will sculpt you. That will stretch you. That will test you. That will push you to reach maybe just a little bit farther.
— Erik Weihenmayer P'22 Adventurer, Author, 2022 UVM Commencement Speaker
519
FALL 2022 | 5
Sensor Cloud Network Research Could Lead to Fewer Falls, Better Quality of Life
INNOVATION | Reducing falls for multiple sclerosis patients could be among the outcomes of the University of Vermont’s participation in Medida ta’s Sensor Cloud Network.

Researchers record realtime data from graduate research assistant Brett Meyer's body as he exercises. These data can help early detection of fall risk in patients with multiple sclerosis.

“We are leveraging tools and tech nology to advance our work in the development of fall risk detection in the multiple sclerosis population, a disease that affects 2.3 million patients worldwide, 50% of whom will experience a fall that negatively impacts their quality of life,” said Ryan McGinnis, associate professor in the Department of Electrical and Bio medical Engineering and director of UVM’s M-Sense Research Group, which develops innovative health technologies with partners in engineering, medi cine, mental health, and movement science.
UVM is joining the Sensor Cloud Network as part of Medidata’s rapidly expanding approach to patient care. Medidata, a Dassault Systèmes company, has announced that AliveCor, Aural Analytics, Biobeat, Blue Spark Technologies, Glooko, Indie Health, University of Arizona, Carnegie Mellon University, University of Rochester, and University of Vermont
are now part of the first cross-sector collaboration focused on solving the challenges related to sensor integrations, standardization of sensor data, and the development of novel digital biomarkers and algo rithms. These will help to create new digital end points that could translate into more effective treat ments and better health care for patients.
Fall risk detection is just one of many potential applications. As one of the health technology inno vators involved in the network, UVM is at the fore front of revolutionizing patient care and positive outcomes. The University has emerged as a leader in biomedical research in recent years, through its ABET-accredited Biomedical Engineering program, which is unique in its field because of its proxim ity to the University of Vermont Medical Center (UVMMC), and the launching of its vibrant Center for Biomedical Innovation. Through its work with the Sensor Cloud Network, UVM builds upon its groundbreaking research in the biomedical arena.
The Sensor Cloud Network, which includes con tract research organizations (CROs), device manufac turers, drug and vaccine developers, analytics compa nies, and academic institutions, creates opportunities
6 | UVM MAGAZINE BAILEY BELTRAMO
| THE GREEN
for data scientists to refine, test, and deliver physiological algorithms with clinical mean ing at scale. Examples include refined motion parameters like gait, cardiovascular metrics, metabolic insights, and clinical grade speech analytics.
“The Sensor Cloud Network is allowing us to explore the combination of patient reported outcomes and medical grade wearables data in remote settings at scale to better understand this problem and to develop a digital interven tion,” McGinnis said.
“As the use of sensors in clinical trials is pre dicted to reach 50% by 2025, we are focused on making Medidata Sensor Cloud the industry standard for collecting and analyzing medical grade sensor data,” said Ben Schlatka, vice pres ident, Digital Biomarker Solutions at Medidata. “We are excited to work with a diverse group of partners to help shape the future of patient data collection and analysis across a wide variety of therapeutic areas.”
Spatial Analysis Lab Helps First Responders Take Flight

COMMUNITY | When an accident or natural disaster happens there are a lot of questions that need to get answered as quickly as possible. First responders arrive on the scene and assess, but when the situation is in a hard-to-reach location, or an unprece dented disaster has occurred, it can be difficult to act fast. UVM is helping to enhance the way first responders and emergency personnel assess and react to accidents and extreme weather events with Uncrewed Aircraft Sys tems (UAS or drones).
A FEMA-funded program hosted by the UVM Spatial Analysis Lab brought drone training to 15 emergency-re sponse roles across Vermont in early August 2022. The mix of public safety, firefighting, emergency management, search and rescue, and agriculture and natural resource personnel spent two days learning about UAS technology, flying drones on campus, and assess ing drone-gathered data in the lab.
The program received vital support from U.S. Senator Patrick Leahy (D-VT) and was able to take place at UVM because of the institution’s ASSURE Core Member status, achieved in fall 2021. ASSURE is the FAA’s Center of Excellence for UAS Research and is the lead on the FEMA first responder train ing project. This workshop will serve as a model for similar FEMA-funded trainings that will be implemented
across the country.
“Technology is playing an increas ingly important role in disaster response and recovery. I was pleased to support funding that will bolster the work of the University of Vermont, which is leading the way in the North east, in partnership with Vermont Technical College, to support the FAA and ASSURE. This is critical research and development that will help Ver mont’s first responders to save lives and give Vermont businesses access to cutting-edge drone technology,” said Leahy.
This collaborative effort is just one of many drone programs happening at UVM. The Spatial Analysis Lab, housed in the Rubenstein School of Environment and Natural Resources, has grown substantially over the past eight years and now instructs and employs nearly 40 students and staff. In addition to supporting disas ter response and assessment, the Lab is home to innovative geospatial research conducted by UVM faculty, postdocs, and students. From assessing urban tree canopy distribution and creating regional heat maps to cap turing aerial footage of harmful algal blooms on Lake Champlain to gauging the severity of defoliation by spongy moth caterpillars, the lab is conduct ing important ecological and environ mental justice research.

FALL 2022 | 7
UVM Research Portfolio Tops $250 Million
RESEARCH | The University of Vermont faculty and staff attracted over a quarter-billion dollars in research funding in the fiscal year ending June 30, reaching a new all-time high. In recent years, the university has focused its research activities on the health of our environment and societies with increased emphasis on building a cam pus infrastructure to support researchers’ work.
“Research at UVM directly addresses the global chal lenges of our time, seeking solutions that benefit Ver mont and the world,” said President Suresh Garimella. “Our scholars’ success in securing external funding reflects the world-class quality of the faculty and our collective ambition to position UVM among the most successful public research universities in the U.S.”
UVM attracted $250.1 million for research last fiscal year, an 8.3% increase from the $231 million total of the previous fiscal year, marking a third consecutive year of robust research growth. For the first time, this year UVM ranks among the top 100 public research universities in the country, according to the most recent National Sci ence Foundation (NSF) Higher Education Research and Development (HERD) survey.
A large component of last year’s growth is the increas ing number of competitive awards UVM faculty proposed and won. Faculty garnered more than 40 awards of $1 mil lion or more compared to 27 in the previous year.
The Larner College of Medicine had another impres sive year of research growth, with over $108 million of research awards, funding projects that address the ever-evolving health care challenges of Vermont and beyond. Recent grants directly support the Vermont Center for Cardiovascular and Brain Health, the Ver mont Center on Behavior and Health, and the UVM Center for Biomedical Shared Resources.
In total, the Larner College of Medicine earned 400 research awards in fiscal year 2022, 52% of UVM’s 798 total awards. This represents an 8% increase from the year before. But research activities are increasingly spread across multiple colleges and schools, includ ing the College of Agriculture and Life Sciences, the College of Arts and Sciences, the Rubenstein School of Environment and Natural Resources, the College of Engineering and Mathematical Sciences, the Col
lege of Education and Social Services, and the College of Nursing and Health Sciences. Together, this group accounted for 48% of all awards and 50% of total spon sored research funding.

“Looking at the variety of academic disciplines win ning increasing support for research, it’s easy to see why UVM is now among the top 100 public research universities in the United States,” said UVM Vice Presi dent for Research Kirk Dombrowski.
“As we continue to build upon our research strengths, expanded funding and more and more innovative approaches are fueling the UVM research engine,” said Dombrowski. “That engine, in turn, drives sustained economic development in Vermont and will strengthen our economy and quality of life in the state in ways we have yet to see.”
An important aspect of economic development is UVM’s focus on corporate partnerships and technol ogy commercialization. UVM Innovations’ gross reve nue from technology transfer opportunities and UVM startups topped $1 million for the first time thanks to the spin-off of Packetized Energy, acquired by Energy Hub in March.
UVM’s growing list of corporate partners includes Mass Mutual, Agilent Technologies, Seventh Genera tion, and Global Foundries. UVM recently dedicated the Agilent Laboratory for Chemical Analysis, a hub for advanced instrumentation that will be a valuable tech nology resource for local and regional businesses. The lab was made possible by the partnership with Agilent.
As the state’s land grant university, supporting and increasing economic vitality in Vermont is one of the university’s top strategic imperatives.
Andrew Crompton '23 examines a tray of purple-stained human cancer cells in a Stafford Hall research lab run by Nimrat Chatterjee. Crompton's independent research supports the lab's larger mission of "reducing or inhibiting cells' resistance to cancer therapies."
| THE GREEN
8 | UVM MAGAZINE

BAILEY BELTRAMO
Moving the Needle
HEALTH | Thanks to a $5.5 million investment from the Bernard Osher Foun dation, UVM Integrative Health and Inte grative Therapies at the University of Ver mont Cancer Center joined the nationally recognized Comprehensive Pain Program this summer to become the Osher Center for Integrative Health at the University of Vermont. The powerful connection places UVM among an international network of 11 academic institutions—ranging from Harvard and Northwestern to the Uni versity of Washington and UC San Fran cisco—in the Osher Collaborative for Inte grative Health.
Led by Dr. Jon Porter, founding med ical director and division chief of com prehensive pain management, Cara Feld man-Hunt, associate director, Dr. Kim Dittus, medical director of oncology sup portive services, and Educational Program Director Karen Westervelt, the Osher Cen ter will work to promote whole patient care, research, education, and health policy centered on treatments that incorporate proven methods from a variety of fields complementing allopathic medicine.
The Osher Center will be housed in enhanced educational and community spaces on UVM’s main campus and in the South Burlington clinical facilities of the Comprehensive Pain Program, which brings together modern medicine, evi dence-based integrative therapies, and a group-based curriculum to address the challenges experienced by those who experience chronic pain. The Center’s additional clinical sites include Integrative Therapies at the UVM Cancer Center (offer ing acupuncture, yoga, massage, Reiki, gardening, health coaching, culinary med icine, and group medical visits for adults with cancer) and the UVM Children’s Hos pital (offering massage and music therapy for children and their caregivers), and an
— Patricia Prelock
integrative health and wellness coaching faculty practice offering services to UVM and UVM Medical Center employees.

A primary goal of the Osher Center is to work toward eradicating disparities in the delivery of integrative care. Because research related to the efficacy and cost-effectiveness of integrative therapies is an important step toward improving insurance coverage for them, the Center will serve as a hub for research and policy development. The Cen ter’s policy arm will capitalize on Vermont’s health care reform progress and the goal of
achieving greater health equity, particularly in rural and underserved communities. Through membership in the Osher Collab orative, the Osher Center will seek insight into the use of integrative health practices with diverse populations to ensure health equity and address health disparities for chronic conditions among Chittenden County’s growing racially and ethnically diverse population and Vermont’s more than 50% rural, socioeconomically diverse population statewide.
Integrative medical education and a biannual integrative pain management con ference will also be offered through the new Osher Center. Practitioners, faculty mem bers, researchers, and students from UVM’s College of Nursing and Health Sciences and Larner College of Medicine will work together through the network to serve the patient populations and clinics of the UVM Medical Center, the UVM Cancer Center, and the entire UVM Health Network.
“UVM and UVM Medical Center have an important leadership role in the deliv ery of care in our region and the conversa tion about making quality care more acces sible to the community,” said UVM Provost and Senior Vice President Patricia Prelock, who will oversee Osher Center operations. “The Osher Center will showcase UVM at its best—building a healthier society.”
10 | UVM MAGAZINE SALLY MCCAY
| THE GREEN
UVM and UVM Medical Center have an important leadership role in the delivery of care in our region.
“
UVM
Provost
and Senior
Vice President
“Go talk to Joe.” That’s a line that many UVM students in crisis have heard over the years. Joseph Russell grew up in Kingston, Jamaica; has worked with young people in both colleges and high schools; and joined the UVM staff in 2005. Today, he is the assistant dean of students within the Office of the Vice Provost and Dean of Students. His calm, compassionate manner—and deep well of knowledge about mental health concerns, roommates in conflict, financial crises, substance abuse, family tragedies, academic struggles, and other problems that afflict students—make his office a key stop on the path to help. We stopped into this office in Nicholson House—a remarkably inviting place, with big windows, soothing corduroy armchairs, bright photos, and warm lights—to have our own talk with Joe.
 Joseph Russell ASSISTANT DEAN OF STUDENTS
Joseph Russell ASSISTANT DEAN OF STUDENTS
Many students come into your office and sit down here on this couch. What brings them in?
RUSSELL: The majority of students who end up in my office are going through some distress or crisis: “I’m losing sleep. I’m not able to study. I’m no longer going to class. I can’t get along with my roommate. There’s trouble at home.” I hear about many challenges including depression and anxiety. My job in leading the UVM CARE Team is to be a point of support across a whole bunch of issues—to help students navigate UVM systems and get them connected to resources or help problem-solve. Most often that’s mental health related but whatever the issue might be—anything that gets in the way of students being able to live, love, laugh, learn, and succeed. I work to connect them to the right person. Is it an academic advi sor? Financial aid? Mental health counselor? Career center? Is it a spiritual concern? It’s case by case. Sometimes, I meet with a stu dent once and they’re off and running. Other times, I meet with a student weekly, set small goals, and check in consistently. Are things getting better or worse? What else do we need to try?
College has long been a huge transition for many young people. But in the wake of COVID-19 and a raft of global troubles, it has become even more challenging. Nationally, 40% of college students report feeling so depressed that it’s hard to function. What have you noticed and how is UVM responding?
RUSSELL: We have seen some baselines shift. I'm sure folks in our counseling center and at student health have data to show increased number of appointments, more students being man aged for prescription medications. I think for everyone—not just students, but as staff and faculty as well— baselines around resil ience have shifted, have gotten a bit less robust. Students are more disillusioned. It doesn't take a lot for some students to feel like: “Ugh, when will COVID end?” And they have grown up in a world where every earthquake and tsunami, every war or bombing, is popping up in the palm of their hand. We hear from students that climate change is not this abstract concern. It’s very personal— wildfires, floods, deforestation, plastics in the ocean. Many of our students are super engaged with the world and with politics. We see this mirroring of how the landscape and the political land scape impact our students. And simply stepping onto a campus of 10,000 students sometimes can feel a little overwhelming.
Our north star is to help students flourish—to be healthy, engaged, and successful. The foundation of this is physical and emotional wellbeing that allows students to really engage in the rich fabric of UVM, not just be active in classes, but outside the classroom too, making friends, building a vibrant social life. Learning something new, play behavior, have opportunities to help other people, having a structured way to explore spiritual ity and meaning-making—these are some of the signs we look for in students who are thriving. And we have many programs to help with this. One new one that I’m super excited about, one of the most tangible ways we’re addressing the changes we see in how students arrive and deal with college, is a new pilot program we’re launching: hiring full-time staff who’ll live on campus in residence halls. These staff have mental health backgrounds and can provide support in a tough moment, be on call in the event of an after-hours emergency, and be able to really address the more complicated mental health landscape.
You grew up in Jamaica. How does that show up for you in the work you do?
RUSSELL: There’s a certain amount of representational diver sity, right? Students who might look like me, see me in a place of leadership—and that can be helpful. I try my best, without dis closing too much, to be open about growing up in Jamaica and that I'm a multiracial, gay man living in Vermont and all of what that means—the joys and challenges for my family and myself to be well. Sometimes when I work with students, I invite them to see what that means for me, and how I show up and how I lead with vulnerability. No one has it all down. Everyone goes through struggles. It's how we support each other—and connect with people and resources around us, to help us through those moments—that makes the difference.
IAN THOMAS JANSEN-LONNQUIST 3 QUESTIONS
FALL 2022 | 11
50 Years of Rescue
Halle Sisenwine '24, Emily Haworth '21, Elias Colberg '22 , and Katya Cavanaugh '23 (left to right) stand in front of one of UVM Rescue's two ambulance vehicles.

LEGACY | When Paula Oppenheim ’75 (now Paula Cope) arrived on the UVM campus, from New York City, in the fall of 1971, she was 16 years old. Her father had died suddenly the year before, and “my mother was an addict with lots of mental health issues,” Cope (above) recalls. “She told me, ‘I’m just not into this mother thing, so have a good life.’ And I never saw her again.” Cope became an emancipated minor—“I hid in the dorms during Christmas break because I had no home,” she said.
But that didn’t stop Cope—during her first year of college—from tak ing a full load of courses, starting the first ROTC pro gram for women on cam pus, “falling totally in love with Vermont and UVM,” she said—and co-founding a student-led ambulance corps, UVM Rescue.
Last spring, to celebrate the milestone, Vermont Governor Phil Scott issued a proclamation declaring Monday, April 25, 2022, “UVM Rescue Day.”

“A half-century has gone by and it’s still inspira tional,” says Cope, who now lives in Williston, Vt., and runs a management consulting business. “When I see UVM Rescue on the road, going to a call, and I see those students at the wheel, I feel proud. When I see them at an accident, I breathe a sigh of relief. I know that people are being taken care of well.”
Cope gives her classmate (and then-boyfriend) John “Jack” Schmidt ’75 all the credit for the idea. “We were eating in the Waterman Cafeteria—it doesn’t exist anymore—and he showed up at dinner with a whole bunch of catalogs for all the equip ment you need for an ambulance. He threw them down on the table and he’s like, ‘we gotta start a res cue squad.’”
Cope wasn’t sure. “Do we need this?” she won dered. But during that time, several arson fires tore through Burlington, “taking down the Cathedral of St Paul's, the Catholic cathe dral, the Mayfair Store on Church Street, one of the theaters. They were huge fires,” Cope recalls. “We felt like Burlington Rescue was alone—and UVM students, we could help.”
Cope, Schmidt, and their friend Stacey Lazarus ’75 soon were taking some of the very first EMT classes offered in Vermont and making a case to the university’s leader ship for buying an ambulance. “We thought, for sure, they would just say, ‘you freshmen, like, you silly kids?’ But they took us seriously,” Cope says.
In July 1972, after months of planning, “we picked up the new truck,” Cope says. “Jack drove, I was in the back, Stacey was in the passenger seat; it was a crazy feeling. We went down Shelburne Road, running the lights, testing the siren. We wore white
JOSHUA BROWN
Use the camera on your phone or tablet to scan this QR code, or go.uvm.edu/rescuevid to watch a video about UVM Rescue. 12 | UVM MAGAZINE
lab coats because we didn’t know what our uniform was going to be.”
A few days later, they got their first emergency call. “It was another big fire. It was terrifying. We were still in our lab coats and we had absolutely no equipment in our truck at all—like not even a BandAid. But we had a license to transport,” Cope recalls. “One of the firefighters said, ‘bring this guy to the hospital.’ And they threw open the back doors, we pulled out our gurney, strapped this guy in, and we did lights and sirens up to the hospital.”
UVM Rescue was launched that fall semester of 1972—a 100%-student-led ambulance service, staffed 24-hours-aday, 7-days-a-week, year-round—“for fifty years,” Cope says. Schmidt was the first director of operations, Lazarus was the first training officer—and Cope was the first personnel officer and first woman on UVM Rescue.
The ambulance was stored in the barn behind Wheeler House, at the time the Wasson Infirmary, near the corner of Prospect and Main Street. When an emergency call would come in, “we’d jump into combat boots, with zippers in them, and run down the icy stairs from the infirmary,” Lazarus recalls. “You had to have wheels out of the garage in under a minute.”
Cope is like generations of students who join UVM Rescue when she says, “It changed me. It gave me a place because I didn't have a place in my life at that time. It gave me a constant set of friends I could rely on and that I knew needed to rely on me, every shift, every day, with every call. You have to work together, you have to rely on each other.”
Cope survived a traumatic childhood— and directed her teenager energy to help ing other people. “My grandmother was a huge influence on me,” Cope says. “She said ‘if you see something that could make a situation better, could help another human, then help. Don’t just walk by and think someone else is going to make it better. You are.’ And that’s why I—we— started UVM Rescue.”
State Adds $10 Million to UVM Appropriation
VERMONT | The Vermont General Assembly’s Omnibus Appropriations bill, signed into law in June by Governor Phil Scott, appropriates an additional $10 mil lion to the University of Vermont.
The additional investment—together with UVM President Suresh Garimella’s commitment to keeping tuition frozen for a fourth consecutive year—bolsters efforts to keep UVM affordable to families in Vermont.
“The University of Vermont values its unique role as the state’s flagship institu tion and land grant university,” said Gari mella. “We deeply appreciate the State of Vermont’s expanded investment in our mission to build the brightest possible future for our state.”
programs in all 14 counties of the state as well as medical education. “It’s hard to find any community within the borders of Ver mont that isn’t somehow connected to our growing engagement efforts,” said Gari mella. In 2020, Garimella launched the Office of Engagement, which specifically focuses on building and sustaining part nerships that will grow the economy and connect entrepreneurs with innovations and talent at UVM.
UVM allocates about half of the state’s current $42.5 million appropriation to help meet the financial needs of students, reducing the amount of debt students acquire. Vermonters graduating from UVM carry debt significantly below the national average. Approximately 45% of undergraduate students from Vermont attend the university tuition-free.
The other half of the state’s appropri ation directly supports UVM Extension
Garimella said the increase in the appropriation is a sign of the state’s will ingness to further invest in UVM, which in turn benefits the state. Garimella pointed out some of the ways UVM serves as an economic engine: Each year, more than 1,000 UVM graduates choose to stay in Vermont, lead ing to a measurable brain gain. Nearly 36,000 UVM alumni live and work in Vermont, a signifi cant portion of the total workforce, many of whom are current or future business leaders. UVM attracts $250 million in extra mural support for advanced research. The university’s growing research portfolio builds the state’s intellectual and social capital, attracting talent to Vermont and sparking further innovation. UVM spurs approx imately $1.33 billion of direct and indi rect economic impact based on the most recent study. UVM is the second-largest employer in the state, with annual pay roll over $300 million.
FALL 2022 | 13
| THE GREEN
We deeply appreciate the state of Vermont’s expanded investment in our mission to build the brightest possible future for our state.
“
— Suresh Garimella
UVM President
Three Students Awarded Fulbrights
This year’s student Fulbright Program winners, Ben Will ’22, master's candidate in community development and applied economics Carina Isbell ’20, and Paige Roussell ’22 are headed to Germany, Uru guay, and South Korea respectively to pursue their passions in virology, agro ecology, and linguistics—an ideal trio for the country’s flagship international academic exchange program, aimed at strengthening global connections in a complex and changing world.
“Our university has a storied history of connecting the state of Vermont to countries and cultures around the globe,” said UVM President Suresh Garimella. “This year’s Fulbright fellows show just how well UVM students combine the values of global citizenship with their academic accomplishments.”
Considered one of the most presti gious international exchange programs in the world, the Fulbright Program is unique in its multinationalism involving more than 140 countries and is noted for its merit-based selection process.
More: go.uvm.edu/studentfullbright22
Faculty Fulbrights Span Disciplines, Continents in 2022-23
An impressive, perhaps unprecedented, number of UVM faculty were awarded Fulbright Scholarships by the U.S. Department of State and the Fulbright Foreign Scholarship Board in the 2022-23 cycle. Extending from research to develop small, biodegradable sensors, to supporting elderly as they age, to exploring racialized religious identity, UVM professors are digging in at uni versities and places of study across the globe. UVM writer Josh Brown dropped in on each of these distinguished researchers and teachers to learn a bit more about their Fulbright plans and how their time abroad will contribute to the creation of useful knowledge—and a better, more beautiful, and safer world.
Guggenheim Winner Explores Ideas and Concepts, not Stories
Artist and filmmaker Angelo Madsen Minax explores sex and death—and what happens “when you put them in the same place,” he says.
Minax—an associate professor of time-based media in UVM’s Department of Art and Art History—was recently awarded a Guggenheim Fellowship that will support development of his work and extend its reach.
“Getting this award is a huge honor, one of the best recognitions you can get as an artist or academic in the United States, and I’m pretty stoked about it,” he says. “It will help move my work forward in the world.”
Minax was selected in April by the Board of Trustees of the John Simon Gug genheim Memorial Foundation from among a diverse group of 180 excep tional artists, scholars, scientists, writers, and other highly creative people—out of almost 2,500 applicants.
Learn More:
Gilliam Fellows at Gund
Gund Graduate Fellow Aura M. Alonso-Ro dríguez and her advisor, Taylor Ricketts, Ph.D., professor in the Rubenstein School of Environment and Natural Resources (RSENR) and director of UVM's Gund Institute for the Environment, have been awarded a 2022 Gilliam Fellowship for Advanced Study by the Howard Hughes Medical Institute (HHMI). The prestigious fellowship recognizes exceptional doctoral students who are on track to be leaders in their fields and who are supported by a fac ulty mentor possessing a shared commit ment to advancing diversity and inclusion in the sciences.
It is a rare accomplishment to be named a Gilliam Fellow. In fact, Alonso-Rodríguez and Ricketts are only the second UVM stu dent-advisor pair to receive the fellowship. They join doctoral candidate Erika Bueno (plant and soil science) and Professor Yolanda Chen, who received the fellow ship in 2020.
Learn More:

14 | UVM MAGAZINE
Learn More: go.uvm.edu/facfulbright22
go.uvm.edu/guggenheim22
Learn
go.uvm.edu/gilliam22 | AWARDS + RECOGNITION
Agrotopias: An American Literary History of Sustainability
 By Abby L. Goode '08 Publisher: University of North Carolina Press
By Abby L. Goode '08 Publisher: University of North Carolina Press
In this book, Abby L. Goode reveals the foundations of American environmental ism and the enduring partnership between racism, eugenics, and agrarian ideals in the United States. Throughout the 19th cen tury, writers as diverse as Martin Delany, Charlotte Perkins Gilman, and Walt Whit man worried about unsustainable condi tions such as population growth and plan tation slavery. In response, they imagined agrotopias—sustainable societies unaf fected by the nation's agricultural and pop ulation crises—elsewhere. Though seem ingly progressive, these agrotopian visions depicted selective breeding and racial “improvement” as the path to environmen tal stability. In this fascinating study, Goode uncovers an early sustainability rhetoric interested in shaping, just as much as sus taining, the American population.
Showing how ideas about race and reproduction were central to early sustain ability thinking, Goode unearths an alter native environmental archive that ranges from gothic novels to Black nationalist manifestos, from Waco, Texas, to the West Indies, from city tenements to White House kitchen gardens. Exposing the eugenic foundations of some of our most well-re garded environmental traditions, this book compels us to reexamine the benevolence of American environmental thought.
Free Speech: From Core Values to Current Debates
By E. Thomas Sullivan & Len Niehoff
Publisher: University Press
Often invoked but rarely fully under stood, free speech is the keystone of United States liberties. From New York Times articles, campus protests, and arguments before the Supreme Court, the fundamental right to free speech is entrenched in the history and culture of the United States. But why is it so important? What value has it served throughout the nation's history? How has the Supreme Court interpreted free speech? What did they get right and what did they get wrong?
These are just a few questions for mer UVM president Tom Sullivan answers in his newest book, “Free Speech: From Core Values to Cur rent Debates,” published May 2022.

Through artful prose and a slim, one-vol ume approach, Sullivan and his coau thor—Len Niehoff the from University of Michigan Law School—trace the his tory of free speech in the U.S. through Supreme Court cases, incorporating the right mix of case description, historical context, critique, and storytelling.
Though written for the classroom, “Free Speech” is an accessible introduc tion into the breadth and depth of a fun damental right in the United States.
The Maine Lobster Boat
By Daniel Sheldon Lee '88 Publisher: Down East Books
Frost. Beal. Lunt. Stanley. Rich. If these names don’t bring an image of a lobster boat sliding up alongside a brightly col ored buoy, or racing in heats past cheer ing fans in Jonesport, Stonington, or Rockland for the title of fastest lobster boat, you are in for a treat.
Author Dan Lee ’88 has written a thoughtful and well-researched anthol ogy of the history of the Maine lobster boat in his recent book by the same name. Locals to Maine and the boat-building industry, as well as those from away, will find equal enjoyment reading personal accounts from those who knew the orig inal boat designers and builders, to the modern-day families who continue the tradition in wood and fiberglass. A selec tion of images of boats and boat builders contextualize the chapters. And for those who appreciate technical details, Lee has included line drawings of the evolved keel and rudder design.
If you have yet to visit a harbor east of the Cheese House, this account will make you feel like you have met many of the most recognized names in lob stering and boat building.

FALL 2022 | 15
| BOOKS + MEDIA
Nature Helps Mental Health, Research Says— but Only for Rich, White People?
New study finds troubling lack of diversity— in participants and geography—in fastgrowing field that explores nature's effects on mental health

New research shows that a rapidly growing environ mental science field—which measures nature's effects on human well-being—has a diversity problem that threatens its ability to make universal scientific claims.
The field—which combines psychology and envi ronmental research—has produced numerous import ant studies detailing the benefits of nature, forests, and parks on human well-being and mental health, includ ing happiness, depression, and anxiety. The findings have been popularized by books like “Your Brain on Nature” and “The Nature Fix”, which champion the great outdoors’ health benefits.
But when University of Vermont researchers ana lyzed a decade of research from the field—174 peer-re viewed studies from 2010 to 2020—they found that study participants were overwhelmingly white and that BIPOC (Black, Indigenous, People of Color) com munities were strongly underrepresented. Over 95% of studies occurred in high-income Western nations in North America, Europe, and East Asia—or Westernized nations such as South Africa—while research in the Global South was largely absent. Less than 4% of stud ies took place in medium-income nations, such as India, with no studies in low-income countries.
This narrow sample of humanity makes it difficult for the field to credibly make universal scientific claims, say the researchers, who published their findings today in Current Research in Environmental Sustainability.
| RESEARCH AMPLIFIED IAN THOMAS JANSEN-LONNQUIST16 | UVM MAGAZINE
“This field has great potential to address urgent issues—from the global mental health crisis to sus tainability efforts worldwide—but to do so, we must better reflect the diversity of world's populations, cultures, and values,” says lead author Carlos Andres Gallegos-Riofrío of the University of Vermont's Gund Institute for Environment.
Just one study in Africa? That's WEIRD Gallegos-Riofrío credits a landmark 2012 analy sis of human psychology and behavioral science for inspiring the study. That earlier team, led by Joseph Henrich, highlighted the problem of drawing universal conclusions about human behavior from experiments that primarily used college students from nations that are WEIRD (Western, Educated, Industrialized, Rich, and Democratic). Given that most humans live in nonWEIRD nations, with different styles of perception and reasoning and values, Henrich's team argued that WEIRD studies could not credibly support universal scientific claims.
The UVM team applied Henrich's lens—but dug deeper into the question of ethnicity for studies of nature's mental health benefits. While they expected a Western bias, they were surprised by the level of bias: sample populations were not only primarily from WEIRD countries—but also overwhelmingly white.
Researchers were also surprised that 62% of studies did not report participants' ethnicity at all (although the team acknowledges some studies used anonymized data sources, such as Twitter). Of the 174 studies, only one study occurred in Africa (South Africa), and one study took place in South America (Colombia)—nei ther tracked ethnicity. Only one study focused on North America's Indigenous peoples.
“We hope our study is a wake-up call for this promising field that sparks positive change,” says co-author Rachelle Gould of UVM's Rubenstein School of Environment and Natural Resources, and the Gund Institute for Environ ment. “A more inclusive and diverse field that embraces the research needs of the global community—and the full spectrum of ways that humans interact with the non-hu man world—will ultimately be more impactful.”
In addition to studying ethnicity and geography, the team also explored cultural values. They report that many studies conceptualized the human-nature relationship in human-centered, individualistic, and extractive terms, rather than with concepts like rec iprocity, responsibility, and kinship, which are more common in many Indigenous and other non-Western cultures, the researchers say.
How to expand the field
The team offers several recommendations to broaden the field: more collaboration with diverse communi ties, greater diversity of participants, improved demo
graphic tracking, enhanced focus on the Global South, culturally sensitive experiments and tools, cross-cul tural research training, and an emphasis on equity and justice. Funding agencies and foundations should encourage greater diversity—of study participants and settings—in their funding calls, the researchers say.
The team also highlights the importance of diversify ing environmental science, with better support for stu dents and faculty from diverse backgrounds, and greater collaboration with diverse communities. Research by Dorceta Taylor and others demonstrates that BIPOC scholars are under-represented in U.S. environmental institutions and that the environmental concerns of BIPOC communities are strongly underestimated.
“We need all cultures working together to tackle the global emergencies we face,” says Amaya Carrasco, a co-author and UVM graduate student. “That requires understanding what's universal about the human-na ture relationship and what is culturally specific. Those insights are critical to driving social change and require research to be more inclusive. We need all hands on deck.”
The study is titled “Chronic deficiency of diversity and pluralism in research on nature’s mental health effects: A planetary health problem.” The research team also included Hassan Arab, a graduate researcher at Wayne University.
Over 95% of studies occurred in highincome Western nations in North America, Europe and East Asia—or Westernized nations such as South Africa— while research in the Global South was largely absent.
“
FALL 2022 | 17
UVM PEOPLE
WORKING TO PREVENT SEXUAL VIOLENCE ELLIOT RUGGLES, LICSW, PH.D.
By Joshua Brown
“Some of us were taught to name and voice our desires and society taught us that they'd be listened to. That often boils down to male entitlement. Other folks have been socialized to not be in touch with their own desires and, additionally, if their desire is stated, it may not be respected,” Ruggles says. Traditional self-defense, adju dication, and safety measures are critical, Ruggles notes, but more is needed. “Training in what is sometimes called ‘empowerment self-defense’ can help people to get more in tune with: ‘What are my desires? And what are my bound aries? And how do I communicate those effectively?’” He’s working to bring these kinds of programs to UVM.
Elliot Ruggles wears his heart on his sleeve—almost literally. He points to a drawing on his sweatshirt that shows an anatomically accurate heart. “It’s a piece of pride for me to show my heart, to show up, as Brené Brown says, in a wholehearted way. Wholeheartedness, that’s what I’m talking about.” Then he smiles and laughs and points again to the heart drawing, a muscular, four-chambered organ: “What I love about this one—you probably can’t see if from here—is that this heart has a word on it: human.”
Last February, Ruggles joined the UVM community as the university’s first-ever sexual violence prevention and education coordinator. A graduate of Mount Holy oke College—who later earned master’s degrees in social work and human sexuality education as well as a Ph.D. in human sexuality studies from Widener University—Rug gles uses “he/him” pronouns and “they/them” pronouns. The complexities of gender are of deep importance to Rug gles—as is a view of our common humanity.
“Sexual violence, gender-based violence, and relation ship harm is happening in our community here at UVM. And it happens in a lot of communities all across the country and all across the world,” Ruggles says. “So, I think a lot about: how does this happen? And what can we do to prevent it and support survivors?”
One place to begin, Ruggles thinks, is by pondering desire. “How do we think of ourselves as sexual beings?” he says. “I definitely believe in the power of comprehen sive sexuality education, seeing relationship education as a mandate for global citizenship.” In programs being developed across campus—partially in response to stu dent activism over the last few years—Ruggles is helping to lead peer-education and masculinity education efforts.
One in five women in America have been raped—and 81% of women and 43% of men have experienced sexual harassment or assault, according to the National Sexual Violence Resource Center. “These explicit acts of violence are not uncommon. They're very common. And yet that violence stands on a foundation of behaviors that are even more frequent in our culture,” Ruggles says. “I'm thinking about glass ceilings and ignoring women and femmes; about media representation, including sexually explicit media; about so-called ‘rape jokes’; about ‘locker room talk’ and ‘boys will be boys’ rationalizations; about hyper masculine norms. We need to talk about these things, get educated.”
College is often a time of extensive exploration—and fun. “We all want to have a good time. If we're able to attend to issues of harm that happen within our commu nities, we can ensure that folks actually do, at the end of the night, say that they had fun. I'll be frank some people have fun at the expense of other people's harm.” Ruggles points to the importance of education about consent, alcohol, opting-in to sexual relationships, and networks of men and others standing up against “a culture that goes silent against rape culture,” he says. “Some of those changes might be uncomfortable in order for us to actu ally move to a place where people experience less harm in our communities.”
Conflicts and misunderstandings are part of being human. Ruggles wants to hold perpetrators of sexual vio lence to public account. “We need to listen to survivors and believe them—they’re the canary in the coal mine shouting, ‘Something is not right!’” he says. And Ruggles’ work also seeks to build a resilient, forgiving community at UVM and beyond. “Can we experience conflict, poten tially even experience harm as a result of that conflict, and still move forward together in relationship? These are big questions of the cultural moment that we're in,” he says. “How do we create boundaries for ourselves, and safety, but, at the same time, not dispose of people?”
“I see hopefulness every day,” Ruggles says. “A lot of people, given the chance and skills, do want to be in better relationship with others. Humanity is yearning for it.”
18 | UVM MAGAZINE

FALL 2022 | 19

READY FOR
BUILDING AN ELECTRIC AIRPLANE IN BTV—UVM STUDENTS BRING CLASSROOM LEARNING TO THE FUTURE OF FLIGHT
 Story by Jeff Wakefield • Photography by Bailey Beltramo Additional reporting by Joshua Brown & Ian Thomas Jansen-Lonnquist
Story by Jeff Wakefield • Photography by Bailey Beltramo Additional reporting by Joshua Brown & Ian Thomas Jansen-Lonnquist
Most of her internship is spent doing hands-on work in the work shop at Beta Technologies. Today Bella Rieley '23 returns from laser scanning the wing of an aircraft to see if a light she has 3D-modeled will integrate into the physical design of the vehicle.

22 | UVM MAGAZINE
When the coronavirus outbreak brought Bella Rieley home to Williston, Vt., in 2020, after two years at a major univer sity in Boston, she thought her education was “derailed.” Then, influenced by a family friend who worked at the company and raved about it, she took a year off to intern at Burlington-based Beta Technologies, a super nova in the emerging field of electric aviation.
The experience “was so groundbreaking in my education that I couldn’t let it go,” she says. “So I transferred to UVM.”
Now a senior mechanical engineering major, Rieley, who continued her internship after enroll ing, couldn’t be happier in her new educational set ting. “What you learn at UVM is conceptual, but everything is applicable to what I do at Beta. It’s super satisfying.”
Rieley isn’t the only UVM student experiencing an educational and career-building high at Beta. The company is virtually an adjunct campus of the uni versity, hosting nearly 40 UVM interns over the past two years.
Not your father’s internship
Internships at Beta bear no resemblance to the mind-numbing, clerical variety of earlier eras.
For starters, the unpaid internship is an unla mented artifact of the past; today’s student interns, at Beta and elsewhere, are paid for their time. And fittingly for paid employees, they are given signifi cant responsibility.
Imbedded in Beta’s workplace philosophy is the idea that students should interact with the com pany’s seasoned engineers as near equals. Mixing their “unbridled creativity,” says Beta CEO Kyle Clark, with the “experience and battle scars of older engineers” is the only way forward in a field that is inventing itself as it goes along.
“The mentality is: if you're willing to take on responsibility and show that you can do it, the com pany is your oyster,” says Vincent Moeykens, a com puter science major and math minor who interned at Beta for four years, graduated from UVM last spring, and now works for the company.
Moeykens was quickly a key member of his team, helping program the company’s simulator, used both to virtually introduce and test new systems in its air craft and to train pilots on flying AVA and ALIA. Both eVTOLs, true to their name, take off and land like a helicopter but fly straight ahead like an airplane.
Rieley found herself in the thick of things from day one.
It’s easy to see what attracts them. Beta’s para digm-shattering eVTOL (for electric vertical takeoff and landing aircraft) prototypes—AVA in 2019 and the more advanced ALIA in 2020—have taken the industry by storm. Venture capitalists and other funders have raised over $800 million to support the company, a staggering sum for a Vermont-based startup that incorporated only in 2017.

And the New York Times, Washington Post, Wired, Bloomberg, CNBC, and a dozen other top media have all given the company marquee coverage for its suc cess in addressing a challenge that is both daunting— electric aircraft must be so efficiently designed that they overcome the weight of batteries and can log long flight times—and urgent. Global aviation accounts for about 1 billion tons of CO2 per year, more than the emissions of most countries, including Germany.
“My mentor was pivotal in forcing me to figure out how to use my hands, how to use my brain and how to problem solve,” she says. Early on she was asked to operate a CNC machine, an enormous tool for fabricating parts with a fast-spinning rotor that “could have killed me,” she says.

“Working with big machinery is super empow ering, and my confidence just built and built. It was like, holy cow, I can operate that,” she says.
Later in her tenure at Beta, Rieley led the design and build of a second, updated version of a “subscale” remote-controlled flying model of ALIA, an indispensable tool engineers use to safely test new avionics systems.
“It was probably the defining moment for me at Beta,” she says. “It really allowed me to take a proj ect of my own and test my skill sets and run with something.”
“What you learn at UVM is conceptual, but everything is applicable to what I do at Beta.
It’s super satisfying.” –Bella Rieley '23 FALL 2022 | 23
Bella Rieley ’23, Shannon Murphy ’22, and Vincent Moeykens ’21 (left to right) have contributed to the design of ALIA, Beta Technologies eVTOL (for electric vertical take-off and landing aircraft) during their internships, and now for Murphy and Moeykens, in their full-time jobs.
Better prospects, better learning
Why does it matter, exactly, that Beta (and other Burlington tech firms: see sidebar) offer so many high-grade internships to UVM students?

UVM’s commitment to expanding qual ity internship opportunities—across all its colleges and schools—is part of the univer sity’s pledge to ensure students have reward ing careers after they graduate. In 2020, nearly 70% of interns were offered full-time jobs by the companies they interned for, according to the National Association of Colleges and Employers. Beta has hired 11 UVM interns into full-time jobs.
about the classroom changes because they have a context for understanding why they're learning what we're teaching them,” she says.
When Rieley was stumped by a chal lenge she was facing at Beta—how to measure the strength of a connecting rod she was fabricating for ALIA’s flight con trol system—she remembered back to a mechanical engineering class she’d taken.
For a refresher, she contacted her profes sor, Dylan Burns, and had a productive talk that helped solve her problem.
SEE IT IN ACTION.
Use the camera on your phone or tablet and this QR code, or visit go.uvm.edu/bella to watch a video about Bella's Beta internship.
But internships improve more than the career prospects of students, says Linda Schadler, dean of the College of Engineer ing and Mathematical Sciences. They also add immeasurably to their learning.
“What you find, after a student has done an internship, is that their attitude
As Schadler predicts, the experience will make Rieley a more engaged class room learner in the future.
“You know that there's a real-world appli cation for what you're learning, as opposed to a flat 2-D picture on a textbook page,” says Rieley. “You think, I could actually work with that at some point in my career.”
24 | UVM MAGAZINE
Vermont Values
The challenge of the work, and the company’s skyrocketing success, are part of what attract UVM interns in droves to Beta.
But its ambitious mission to address a looming environmental crisis is just as important.
“Beta is trying to transform the face of trans portation, to help save the environment,” says Rieley, who hopes to work at the company after graduation. “Being located in such an incredible environment, Vermont, speaks to its mission. Beta is homegrown. We're local. We're doing this not just for ourselves; we're designing this aircraft so that everyone can experience what we have in Vermont.”
For Shannon Murphy, a just-graduated mechanical engineering major who worked in the company’s 3-D printing lab prototyp ing parts, Beta’s environmental focus meshes with her own belief system and goals.
“Beta wants to do bet ter for the environment and create and reinvent that people think about airplanes and travel,” she says. “And they want to educate people about that. I fit in with the education role; I want to teach people how the airplane works, why we're doing it.”
Another aspect of the company that’s a nat ural draw for ecology-minded UVM students? Its emphasis on “bio-mimicry”—modeling engineering on natural biological systems.
ALIA’s aerodynamics, for instance, are inspired by the efficient wing and tail struc ture of the arctic tern, which migrates longer distances than any other bird on earth.

Rieley and Moeykens, both trained pilots (Rieley earned her wings by taking advan tage of a Beta perk, free flight lessons for employees), are attracted to Beta for yet another reason: the beauty of the company’s aircraft in flight.

“ALIA looks really natural,” Moeykens says, “like it belongs in the air.”
ALIA takes inspiration from the Arctic tern, a small bird known for migrating further than any other bird. As a side project during her internship, Bella created this metal-cut sillouette of ALIA overlayed with the skeletal structure of an Arctic turn. Two of which are on display in the halls of Beta.
"I want to teach people how the airplane works, why we're doing it."
–Shannon Murphy '22
FALL 2022 | 25
Green Mountain Ties
Beta CEO Kyle Clark graduated from Harvard with a degree in materials science, but Clark and Beta have strong Vermont—and UVM—ties.
For more than 25 years his father, Tobey, ran the university’s Instrumentation and Modeling Facility, which creates custom equipment that UVM science, medical, and engineering faculty use in their research experiments. IMF fabricated parts used in Beta’s early prototypes.
UVM engineering faculty also contributed sig nificantly to the control system design of Beta’s aircraft, Clark says. And the company’s first hire was a UVM student, drawn from a hands-on engi neering class Clark was involved with.
and a range of social issues, and about technolog ical things. The largest island microgrid the U.S. Department of Energy has seen is in Rutland.”
Ultimately, though, the proof is in the pud ding, Clark says. “We've come up with the high est-performing electric aircraft in the industry— right here in Vermont.”
Beta’s business strategy is as innovative as its engineering. Almost all companies developing eVTOLs conceive of the crafts as “air taxis” provid ing short hops to passengers in major cities, which could present challenges for Federal Aviation Agency approval. Beta, by contrast, is targeting the e-commerce-driven cargo market, greening up the fossil-fuel-drenched transport of packages by companies like Amazon and UPS. UPS has ordered 10 of Beta’s aircraft with an option for 140 more, and Amazon has invested heavily in the company through its Climate Pledge Fund. Beta is targeting 2024 for FAA approval.
Why is Beta in Vermont and not in San Fran cisco or Boston? Clark is often asked that ques tion, especially by funders.
“First of all, I was born here at the UVM Med ical Center; I love it here,” he says. “I also think Vermont is a state of firsts. If you look back, we have a long history of being open-minded—about (the immorality of) slavery, about gay marriage
UVM students are certainly happy with Clark’s geographic preference.
“I just can't believe that I work here and that this is my job and that's my office,” Murphy said of her internship. “It doesn’t seem like Beta would be here in Vermont. And then all of a sudden you walk in, and there's just all these amazing things happening—right down the street from where I go to school.” UVM
Vince Moeykens
'21 (left), Shannon Murphy '22 (center), and Bella Rieley '23 (right) stand in front of ALIA, Beta Tech nology's cutting edge electric aircraft.

"The mentality is: if you're willing to take on responsibility and show that you can do it, the company is your oyster."
–Vincent Moeykens, '21
26 | UVM MAGAZINE
STARTUP CITY
Beta may be the crown jewel in Burlington’s emerging new tech ecosystem, but it’s not the only gem.

In the last five years, since a New York Times story heralded Burlington’s emer gence as a tech mecca (A ‘Smart’ Green Tech Hub in Vermont Reimagines the Status Quo), the area’s “innovation activity is five to 10 times greater,” says David Bradbury (Busi ness, ’88), president of the Vermont Center for Emerging Technologies (VCET), the tech incubator and co-working space featured in the Times story.
“There are so many Vermont tech com panies now that offer internships for our stu dents, it’s amazing,” says Holly Fosher, career readiness program coordinator in the College of Engineering and Mathematical Sciences.
To help students make sense of Burling ton’s increasingly rich tech tapestry, Fosher encourages them to join VCET, which waives membership fees for students, and to ex plore Hula Lakeside, a spectacular new tech incubator and co-working space that opened on the shores of Lake Champlain in 2020.
Thanks to VCET, Hula, innovations at UVM, and the influence of Vermont’s leg endary entrepreneurial culture (think Ben & Jerry’s, Burton Snowboards, Seventh Gener ation), many tech firms in greater Burlington are startups.
The area doesn’t lack for large, estab lished companies that offer internships to UVM students, from chip manufacturer Glob al Foundries to software powerhouse Dealer. com to biotech giant Agilent Technologies.
But students who want to fast-track their learning and career opportunities often choose to intern, and work, at small com panies just establishing themselves, where they can perform a variety of functions, have a major impact, and create strong re sume entries.
2022 UVM graduate Skylar Bagdon, vice president of business development for startup Verde Technologies, is a case in point.
Verde has boggling potential. The com pany makes pliable, inexpensive, lightweight solar panels based on the groundbreaking “thin film” research of UVM Physics Chair Randy Headrick, which could accommodate many more homes and businesses than con ventional rigid solar panels, enabling the company to tap a $66 billion market.
To help the company reach that vast po tential, Bagdon, a self-designed sustainable technology commercialization major at UVM, wears every hat on the hat rack, meeting with lawyers, real estate developers, financial planners, grant writers, federal research labs working on solar, and manufacturers over the course of a typical few weeks.
“It’s awesome; I can’t imagine doing any thing else,” says Bagdon, who has an office in the Hula complex.
When he was at UVM, the entrepreneur ial Bagdon was the driving force behind the new Academic Research Commercializa tion, or ARC, program, which is generating even more opportunities for UVM student to intern at emerging tech companies. ARC exploits an obvious, but overlooked, source: UVM faculty innovators like Head rick, who often have brilliant research ideas that could be commercialized but lack the expertise and time to bring them to market.
Working with Corine Farewell, director of UVM Innovations, who selects the most promising faculty projects, and Erik Monsen, Steven Grossman Endowed Chair in Entrepre neurship in the Grossman School of Business, who advises the students, Bagdon and his stu dent colleagues have attracted 17 students to ARC’s paid internship program. Students have worked with three promising faculty projects to date—Verde began as an ARC client—with three more on tap this year.
Verde hopes to follow in the footsteps of another UVM-spawned startup and Hula tenant—Benchmark Space Systems, which makes propulsion systems for satellites. Founded by UVM alumnus Ryan McDevitt (Mechanical Engineering M.S. 2011, Ph.D., 2014) in 2017, the company is growing rap idly and now employs 80, including five UVM alums who began at the company as interns.
Co-working space in VCET's Burlington offices.
Photo: Ian Thomas Jansen-Lonnquist
A YEAR FOR THE AGES
[ STORY BY KEVIN COBURN [
28 | UVM MAGAZINE
W
hat was the greatest year in UVM sports history? Was it 1912, when Albert Gutterson, class of 1912, won a gold medal in Stockholm with a new Olympic record in the long jump? Was it 1931, when undergrad Edith Pritchard ’31 posted 28 perfect scores in rifle and set a Women’s Individual Intercollegiate NRA match record? Was it 1964, when Bobby Mitchell '68 shattered numerous UVM football records and set an NCAA record for rushing attempts and yards per game? Was it 1972, when Barbara Ann Cochran ’78 won gold in slalom at the Olympic Games in Sapporo, Japan? Was it 1996, when the UVM men’s hockey team made it to the Frozen Four with future NHL stars Martin Saint Louis ’97 and Tim Thomas ’97? Was it 2005, when the men’s basketball team defeated #4 Syracuse in the NCAA tournament? Was it 2010, when the UVM women’s basketball team took down Wisconsin in the NCAA tournament—led by Courtnay Pilypaitis ’10, the first NCAA player to record over 1,900 points, 800 rebounds, and 600 assists? Or was it the 20212022 season?
While these historic years, teams, and student-athletes pro vided plenty of excitement and glory, consider the case that the widespread success made this past year the greatest year— of all time—for UVM Athletics.
Here’s the case: UVM teams compiled the university’s bestever collective team winning percentage of .617 while main taining a 3.4 GPA as a department. Along the way they racked up six conference championships and placed second in the America East Commissioner’s Cup. The Catamounts were also fifth out of 71 non-football schools across the country in the Learfield Direc tors’ Cup, which measures overall department athletic success. A record 13 athletes represented UVM and five different countries in the 2022 Beijing Winter Olympics. And a record six teams represented UVM in NCAA championships. All of this during the middle of the global COVID-19 pandemic.
What year could top that? If you have others to propose, we’d love to hear from you. Drop us a note at magazine@uvm.edu.
And if you need more convincing about the wonders and success of this past year in UVM sports, here’s a sketch:
FALL 2022 | 29
On the slopes, the UVM ski team won its 38th Eastern Intercollegiate Ski Association title and fin ished second in the nation behind only Utah at the NCAA Championships. UVM student-athletes captured three individual national titles at the championships including U.S. Olympian Ben Ogden ’22, who swept both Nordic races, and Mathias Tefre, ’23 who became the fourth Catamount in program history to win back-to-back national titles in the slalom.
November 7, 2021, was an ecstatic day for thousands of UVM soccer fans at Virtue Field as the UVM women’s soccer team won its first-ever America East Conference Championship against New Hampshire.


COVID-19 severely limited the women’s season in 2020— the Cats played just six games, finishing with a 1-4-1 record. Coach Kristi Huizenga’s squad got off to a quick start in 2021, winning three of their first four before dropping back-to-back contests to America East rivals Binghamton and Stony Brook.
“We were disappointed and frankly a little mad at ourselves after the Stony Brook game,” said midfielder Alyssa Oviedo ’22.
“I think that sparked something in us.”
30 | UVM MAGAZINE
The Cats didn’t lose another conference game the rest of the season. UVM defeated UAlbany 4-1 in the semifinal of the conference tournament, and Cricket Basa ’22 scored the only goal of the championship game against New Hampshire in the 80th minute to clinch the conference title at Virtue Field in front of a women’s soccer record crowd of 2,017 fans. The Catamounts advanced to the NCAA Tournament for the second time in program history, but fell 2-0 in a tight contest at Princeton.
As co-president of the UVM Student-Athlete Advisory Council during the uncertain 2020-21 season, Oviedo ’22 was acutely aware of the anx iety student-athletes were experiencing due to COVID. Distancing requirements often removed student-athletes from the essence of successful team play—working out and practicing together. “It was really tough to stay connected,” Oviedo said. “With so many games cancelled we’d say to ourselves, ‘you never know if this is going to be the last game of our season.’”



Oviedo worked to help connect student-ath letes on different teams through events like “Better Together,” which invited athletes to participate in fun, COVID-safe group games at Virtue Field. “We had girls on the lacrosse team and boys on the bas ketball team just taking penalty kicks. We had field hockey girls trying to toss lacrosse balls to each other. It was one way to physically bring student-athletes back together.”
Outstanding team defense and goaltending were the hallmarks of the men’s soccer team early in the season. The Cats reeled off five straight wins with out being scored on, beating Iona, Lehigh, Colgate, Princeton, and UMass by a collective 10-0 score. UVM forwards and strikers increasingly found the back of the net as the season progressed, and the Cats finished with another five-game winning streak, establishing themselves as the two-seed in the America East Tournament. After dispatching NJIT 3-2 in the semifinals, the men’s champion ship game also came down to a single score late in the game. It was Yves Borie’s G ’23 goal at the 68th minute against New Hampshire, a team unbeaten in conference play during the regular season and ranked sixth in the country, that delivered the sixth America East Championship in men’s program his tory and the first for head coach Rob Dow.

“Everyone had the best game of their season,” said Dow of his team’s performance in the final. “At the end of the game there just wasn’t an ounce left for them to give.”
He believes the success of the women’s team was a motivating factor for his players. “It was great to see that our guys were the loudest sup porters of the women’s team on the sideline. It also created a bit of an expectation—‘well, the women beat New Hampshire, so I guess we need to go down there and win too.’”
Other teams and student-athletes were finding new levels of success during the fall semester as well. The women’s field hockey team reached the 10-win mark for the first time in program history, and the Catamounts notched their 10th victory over Maine, a team ranked nationally in the top 25.
FALL 2022 | 31
Despite missing several student-athletes represent ing their home countries during the Beijing Winter Olympics, the UVM women’s hockey team never had back-to-back losses after November. Four UVM women skaters took a late-season sabbatical to Bei jing to follow their Olympic dreams including Natá lie Mlynková ’24, Tynka Pátková ’23, and Blanka Škodová ’22. The trio joined alumna Sammy Kolow rat '19 on the Czech Republic team. Sini Karjalainen '22 competed for Finland, making her Olympic debut against the U.S. team. She brought her bronze medal home to Burlington following Finland’s 4-0 victory over Switzerland. In addition, incoming first-year student Sofie Skott skated for Denmark.
Hockey East Player of the Year Theresa Schafzahl '22, who broke UVM records for most goals and total points in a season, acknowledged that the loss of so many key players at once required adjustments. “In the grand scheme of things, I think it really made us better because it opened up opportunities for younger players who didn’t have as much ice time,” she said.
Reinforced by the returning Olympians, the UVM women finished at 22-11-3, garnering the most wins in program history. They beat Provi dence 4-1 in the Hockey East quarterfinals before falling in the semifinals. At season’s end, Schafzahl and Maude Poulin-Labelle ’22 became the first women in program history to be named Division I CCM/AHCA All-Americans.


Meanwhile the men’s team showed marked improvement as head hockey coach Todd Woodcroft continued to reshape the UVM roster. Last year the Catamounts inte grated 14 new players, and many more talented recruits are on their way to the Gut. UVM lost a total of 12 games by just one goal, suggesting that the team is just a step or two away from being a con tender again.
While the men’s basketball team was estab lishing itself as the clear favorite in the America East, the UVM women were also putting together a memorable year. UVM posted their first 20-win season since 2010. Led by guard Emma Utterbeck ’22 (13.5 points per game) and Anna Olson ’24 (12.3 points a game and a team best 40 blocks,) UVM entered the America East tournament as the three-seed. In their first home playoff game in 21 years, the Catamounts came back from a six-point fourth-quarter deficit to beat Binghamton 65-60. Their season came to an end in the semifinals at UAlbany, the eventual America East Champions.

Mayer Women's Basketball Coach Alisa Kresge believes the success and work ethic of the Vermont men rubbed off on her own players. “This year more than ever I’d walk into the gym and 24/7 I’d see either one of our players or one of the men’s players working. That’s the culture I’ve seen from the men’s team, and now it’s part of our program. Credit to our players—they want to be good,” she said.
The Catamounts were also winners in the swimming pool, finishing with a meet record of 4-3. The team finished third overall at the America East Swimming and Diving Cham pionships. The following week Jackie and Kira Parker ’22 earned AllECAC honors at the three-day ECAC Swimming and Diving Champion ships at the Naval Academy in Annapolis. UVM placed 10th out of 25 women's teams.




FALL 2022 | 33




34 | UVM MAGAZINE
Before the hockey and basketball sea sons wound down the UVM lacrosse teams were already in action, and early signs pointed to a stellar season for both the men’s and women’s squads.

Under sixth-year coach Chris Feifs, the men opened the year with a very competitive effort against Duke, ranked third in the nation at the time. Ten days later the Catamounts defeated Penn State 16-10—it was the program’s first victory against a current member of the Big Ten since 1986. The Cats rolled to a perfect 6-0 conference record and won their second straight America East title before a home crowd at Virtue Field with a 13-11 victory over UMBC. In the NCAA Tournament, the Catamounts hosted their first-ever NCAA tour nament game and dominated against Manhattan 15-3 before falling to the eventual national cham pion, top-ranked Maryland.
Meanwhile the women’s lax squad sprinted off to an 8-1 start en-route to a 14-5 cam paign. Highlights included a 16-10 victory over Boston University, UVM’s first win against the Terriers since 1996. After falling to Binghamton earlier in the season, the Cats defeated the Bear cats in the semifinals of the Amer ica East Tournament 13-12, then followed it up with another thrilling 12-11 win over topranked Albany in the cham pionship game. The Cats trailed late by five goals but outscored the Danes 5-2 in the final quarter.


Grace Giancola ’22, named outstanding player of the tournament, scored the tiebreaker to ice the game in the closing minutes. It marked the first America East championship in program history, and the first time an America East school won both the women’s and men’s conference champi onships in the same season.
Milford, Mass., native Ava Vasile ’23, named to the America East All-Conference First Team in lacrosse in 2021 and 2022, chose UVM among other suitors because of the team culture. “From the first moment I visited the locker room I could really get that sense of family, just the way people interacted with each other.”
That culture was abruptly challenged when COVID-19 made large group practices unsafe. Team members made the best of it, practicing in small group “pods” and holding periodic online check-ins called “Cat Fams.” Vasile said the ath letes looked forward to games, if only because it was the only time they didn’t have to wear masks.
“Sticking together required mental toughness,” Vasile said. She credits her coaches and the athletic training staff for working closely with each athlete to maintain fitness.

“Becca (performance coach Rebekkah Bond) really shaped us into almost a new team. She's just such an amazing strength coach and she just pushes us to be the best we can be,” she said. “And Sarah (Head Coach Sarah Dalton Graddock) is such a great coach and such a good person outside of lacrosse. The coaching staff is a big reason why I came to Vermont.”
In the midst of the historic lacrosse double the Catamounts also hosted the America East Outdoor Track & Field Championships for the third time in program history at the Frank H. Livak Track & Field Facility. The two-day event was highlighted by junior Lauren Triarsi becoming the first Cata mount since 2015 to be crowned champion in the heptathlon, which recognizes the best all-around athlete competing in seven distinct disciplines.
UVM Director of Athletics Jeff Schulman credits student-athletes, coaches, and athletic training staff for maintaining a sense of joint pur pose and teamwork during the bleakest days of COVID-19 restrictions.
“I’m incredibly proud of the way everyone in the UVM Athletics community and our entire campus responded to the extraordinary challenges presented by the pandemic,” he said. “Last year was record-setting in all respects. The success is a power ful testament to the amazing group of student-ath letes, coaches, and staff who are such source of pride for Catamount Country. Our athletic medicine team deserves special recognition for the remark able effort that was put in helping our department navigate through the pandemic and positioning us for such a successful 21-22 season.”
UVM
FALL 2022 | 35
IN FUTURES
Story by Sara White Photogarphy by Bailey Beltramo

INVESTING
FOR DEDICATED STUDENTS, THE GROSSMAN SCHOOL DELIVERS TOP RETURNS
“I volunteered myself anytime I was free for any sort of event, like speaking at orien tation or hosting Student Alumni Associa tion events,” she explained. “I would do my classes, and then every night it would just be hopping from one Teams call to the next.”
Merchant’s drive, fueled equally by curi osity and fear of missing out, offers an ideal complement to the experiential opportuni ties afforded by the Grossman School, from guest speakers and panel discussions to mock interviews with alumni, networking events, case competitions, and site visits to top companies. Entrepreneurship programs encourage students to develop ideas into ventures, and the Professional Engagement & Knowledge Systems (PEAKS) program tracks participation in projects and activities to help students build their resumes.
“I wanted to see what I could get involved in,” said Merchant. “And that's opened so many doors at Grossman.”
The Pitch Merchant’s upfront investment of time led to a teaching assistant (TA) position in BSAD 002 - Professional Development Series I, an uncommon opportunity for a first-year student.
“I was super involved in class my first semester and the professor saw that,” said Merchant.
When she learned that the TA for BSAD 102 couldn't attend class, Merchant offered to help and gained a chance to participate in upper-level course projects, including the Grossman School’s well-known mock interview rounds with local entrepreneurs, community members, and UVM alumni. Her interviewer, from BTV-based Pivot Mar keting, was so impressed that she recruited her for an internship.
Merchant’s experience of the power
of the Grossman School network is not uncommon. Students who’ve competed to solve complex family business cases in the renowned Schlesinger Global Family Enter prise Case Competition are now working at Amazon, GE Capital, Google, Johnson & Johnson, JP Morgan Chase, Morgan Stanley, PayPal, PwC, Unilever, Wayfair, and Zoom, among other companies.
Metrics of Success
Merchant spent the summer mastering paid search optimization on digital ad campaigns at Pivot, developing a portfolio of new skills and certifications and a clearer focus on her business values. The marketing skills she gained will enhance her work this fall as a venture analyst with the UVM Catamount Innovation Fund, a Shark Tank-style compe tition that provides startup capital and con sulting to students with winning business pitches. But what Merchant values most about working with the Catamount Innova tion Fund is more personal.
“At Pivot, a lot of the performance and the success stories are numbers on a screen,” Merchant said. “In the Catamount Innova tion Fund, we run participants through this accelerator program, where we give them rounds of funding based on their meeting business goals and coach them through creating a business plan, business pitches. I love to see more of the human side of it.”
Business Value(s)
Caring for people and the environment and having the ambition to make a posi tive impact on society and the economy are commonly shared ideals among students in the Grossman School, said Pramodita (Dita) Sharma, professor and Schlesinger-Gross man Chair of Family Business in the Gross man School.
Grossman is an AACSB-accredited business program, a credential synonymous with the highest standards in business education and earned by less than 5% of the world's business schools.
FALL 2022 | 37
“It started with a yes, really,” says Lily Merchant ’24 of the success she’s experienced in her first two years as an undergraduate in the Grossman School of Business (GSB).
Grossman is an AACSB-accredited business program, a credential synon ymous with the highest standards in business education and earned by less than 5% of the world's business schools. The school’s consistent success, Sharma believes, can be attributed to stable and visionary leadership, strong sup port from top UVM administrators, the focused dedication of faculty and staff, and generous philanthropic support.
“Faculty are dedicated to top-class teaching, student development and suc cess, knowledge creation, and research activities,” said Sharma, adding that a deeply committed and engaged Board of Advisors supports student career develop ment, academic programs, and experien tial learning.
The undergraduate program com bines depth of knowledge in the func tional disciplines of accounting, business analytics, finance, and marketing with a broad understanding of entrepreneur ship, global business, and sustainabil ity. Experiential learning is supported through student-managed equity and asset funds from generous donors. The program’s specialized concentrations and themes allow for an education well-suited for today’s rapidly changing world, said Charles Schnitzlein, the Ste ven Grossman Endowed Chair in Finance at the Grossman School.
Chief among these changes, said Schnitzlein, is the significant shift in the Earth's climate and the potential to begin to address the damage that's been done over the past few decades through sus tainable business practices. As director of the top-ranked Sustainable Innovation M.B.A. Program, he’s observed that many students come to the Grossman School because of their values and because they have deep concern about sustainability in all of its manifestations, from the environ ment to social justice.
The core theme of sustainable business practices is integrated into all of Gross man’s undergraduate and graduate degree programs, research, and extracurricular activities. Even the Master of Accounting program incorporates sustainable account ing and cryptocurrency knowledge with foundational concepts in auditing, taxa tion, and law.

From Merchant’s perspective, GSB was the ideal choice to meet her career goals. ("I knew my future self would thank me," she says.) She’s come to rely on the con nections she’s made, her faculty mentors, and guidance from the academic advisors who have helped her develop a plan for all she wants to accomplish as a business administration major with a marketing concentration, global business theme, Spanish minor, and involvement in 12+ organizations on campus.
— Charles Schnitzlein Steven Grossman Endowed Chair in Finance
Future Forecast
Merchant soon hopes to add experience with UVM’s Academic Research Com mercialization program—an innovative new incubator connecting UVM pro fessors with talented students who can help bring their ideas to market—to her resume. She’s got an internship on tap this fall with UVM Athletics, analyzing ticket sales data. Long-term, she’s focused on a career in consulting, project man agement, or real estate.
“I'd love to run a business someday,” she says, ticking off a list of possibilities from ice cream sales to honing her inter ests in fashion and film. “I think everyone has a secret dream to be an influencer,” she adds. “Who knows?”
"Many students come to the Grossman School because of their values and because they have deep concern about sustainability in all of its manifestations, from environmental to social justice"
38 | UVM MAGAZINE
With motivation like Merchant’s and the assets the Grossman School provides, that's a venture with potential for a high rate of return.

The Bottom Line
Visions like Merchant's become reality in part through philanthropic investment in the University of Vermont’s Grossman School of Business. Steven Grossman ’61 recently made a second historic gift that will launch an era of excellence for the school that bears his name. Grossman’s personal philanthropic investment builds upon the success of the Grossman Family Foundation’s historic 2013 gift that transformed business education at the university. This original gift created great momentum for further invest ments in the quality of the Grossman School faculty, facilities, programs, and scholarships. A series of matching gift challenges sparked an additional $18.8 million in philanthropic contributions from more than 350 other donors. When the latest gift’s $5 million challenge match component is met, Steven Gross man and the Grossman Family Foun dation will have contributed or incen tivized gifts to the Grossman School in excess of $75 million.
Donors have helped elevate the school's status among business schools in the U.S. and around the world. The Gross man School was recently ranked among the top nine business schools internation ally and top three in the U.S. for positive social impact by the World Economic Forum, Davos, and included in the top 50 business schools for graduate entre preneurship studies by Princeton Review. It garnered a Top 10 Better World MBA ranking from Corporate Knights and rec ognition as the top “green MBA” program in the U.S. by Princeton Review. The Fam ily Business Program is ranked among the top 25 in the world and top six in the U.S. by Family Capital. UVM
FALL 2022 | 39



40 | UVM MAGAZINE
Two Centuries of Service
The nation’s seventh-oldest medical school celebrates its bicentennial.

It all comes down to one crucial figure: the patient. A medical school has hundreds of fac ulty, staff members, and students, thousands of square feet of laboratory and teaching space, and millions of dollars in research funding; but all of it exists, ultimately, for the benefit of each individual suffering from some physical complaint whose situ ation can be relieved or eased—a life made better or more bearable.
This year, the story of that relationship at UVM passes a new milestone: the 200th anniversary of the founding of what would become the Robert Larner, M.D. College of Medicine at the University of Vermont, the seventh-oldest medical school in the nation, and the granting in 1823 of the first UVM M.D. degrees.
Story By Edward Neuert
Stereographs by Burlington photographer L.G.

Burnham of medical students posing on and in front of the College of Medicine’s home, circa 1875.
The building still stands south of the UVM Green, and is now named Pomeroy Hall after Dr. John Pomeroy, the College’s founder.

FALL 2022 | 41
Early Years
The first and strongest proponent of med ical education at UVM was Dr. John Pome roy. Pomeroy never earned his own M.D. degree. He was, like most doctors of the era, trained through apprenticeship. But his skills were legendary: he once performed a tracheotomy aboard a canal boat on Lake Champlain using a knife and the hollow tube of a goose quill pen.
In the years after the War of 1812, Pome roy began the first formal medical lectures at the university, and in 1814 he was one of the three founders of what is now the Vermont Medical Society. In 1822, along with the prominent medical educator Dr. Nathan Smith, he would help to organize the first formal series of lectures at what would become the College of Medicine.
The early years of what was then com monly known as the Medical Department were rocky ones. The fact that Dr. Nathan Smith agreed to be part of its organization undoubtedly impressed the leaders of the fledgling university. Smith was one of the leading physicians of the day, and by 1822 had already organized medical schools at
both Yale and Dartmouth. What Smith helped organize could most accurately be described as a college of medicine at UVM, not of it; indeed, until 1899, the college was a separate legal entity controlled by its fac ulty and supported by fees from the sale of lecture tickets they personally collected from their students.
Enrollments fluctuated widely from year to year. In those days there were other outlets for medical education in the state, at Castleton and Woodstock. When the economic depression called the Panic of 1837 hit the U.S., the school was forced to shutter for 17 years. Revived in 1854, it slowly built back its faculty and, as the other Vermont medical schools closed, expanded its student body. In 1879, the Mary Fletcher Hospital was founded adja cent to the UVM campus—at last provid ing a local teaching hospital for students.
New Homes, New Problems
By the 1880s, the college had outgrown Pomeroy Hall, the brick building, still standing south of the UVM Green, that had been its home since 1829. Local philanthro pist John Purple Howard refurbished and donated a mansion at the corner of Prospect and Pearl Streets to be the new home of the college, complete with its first semi-circular lecture hall. It was in that hall that an errant cigar butt, dropped into the space under the seats, sparked a fire that consumed the building on the morning of December 3, 1903. The university swiftly rebuilt on the site. By the summer of 1905 the third “permanent home” of the college was com pleted—the building, now known as Dewey Hall, that still stands north of the Green.

The fire was not the last of the school’s troubles. In 1910, the Carnegie Foundation for the Advancement of Teaching, as part of an effort to reform medical education, appointed Dr. Abraham Flexner to examine all North American medical schools and suggest improvements. Flexner’s report was a body blow to UVM. He concluded that New England needed only two medi cal schools and recommended closing all but Harvard’s and Yale’s. (His report also led, tragically, to the closure of many of the nation’s historically black medical schools.)
Dean Henry Tinkham had no intention of closing UVM’s medical school but did act on many of Flexner’s recommendations,
1800 1822 Nathan Smith delivers first formal lecture at UVM “Medical Department” 1899 UVM assumes administrative control of what is now the College of Medicine 1905 The College’s third home, today known as Dewey Hall, is completed 1804 Dr. John Pomeroy begins teaching medicine to students in his Burlington home 1885 First African American UVM medical student, Thomas James Davis, graduates 1903 The College Building is destroyed by fire Cornelius McKane, M.D., was the third African American student to graduate from the UVM College of Medicine. A detailed view of the Class of 1891 photograph shows Dr. McKane standing in the middle of the upper step of the staircase. 42 | UVM MAGAZINE
Part of the UVM medical student body gathered in March of 1900 for this pho tograph in the amphitheater of the College of Medicine building at Pearl and Prospect Streets. Less than three years later, a fire that started in this room would consume the entire structure.

FALL 2022 | 43
Jackson J.W. Clemmons, Ph.D., M.D., now emeritus professor of pathology, joins the College as the second African American faculty member. He will teach
conduct research
than
Pediatrician Carol Phillips, M.D. becomes first female department chair at the College
revamping the curriculum and hiring new permanent faculty. It was not the last crisis the college would face. By the 1930s, fac ulty numbers had again slipped, and the American Medical Association threatened to revoke the school’s accreditation. A fac ulty committee led by radiologist A. Bradley Soule, M.D.’28 led an effort to again reorga nize, and the crisis was averted.
The Modern Med School
By the late 1950s it was clear that, to remain a viable medical school, the college would have to grow both its student body and its research enterprise. After an extensive fund raising drive involving hundreds of alumni, and a major grant from the Irene Heinz Given and John LaPorte Given Foundation, the college’s new home was completed in 1968, with new lecture halls and extensive laboratories in its 235,000 square feet of space. It was named in honor of the Givens.
Over the years, in the laboratories of Given, and more advanced facilities added in early in this century, researchers would bring forth new knowledge in many areas. Now, each year more than $100 million of grant-supported biomedical research takes place in laboratory, clinical, and com munity settings, work that brings greater understanding of disease and wellness,
and new, more effective treatments for cancer, and in the areas of cardiovascular, immunobiology and infectious disease, metabolic, neuroscience, and pulmonary and environmental disease, as well as health services research and education, outcomes research, and quality improve ment. This fall, scientists moved into the latest addition to the medical campus, the 62,500-square-foot Firestone Medical Research Building, named for the family of its lead donor, Steve Firestone, M.D.’69.
Growth and Change
Along with an increase of the “footprint” of the college came growth of and change in the student body. Today, there are about 124 medical students in each class. At the same time, the number of graduate students working in biomedical labs has grown to more than 300.
The diversity of students had a much slower and intermittent record of growth. It took a century for the first female medi cal students to be admitted—to the Class of 1924. And for more than 50 years after that, women were only rarely granted admis sion. Only in the 1970s and 80s did this begin to change, to the point where about 60% of the most recent medical classes identify as female.

TODAY 1962
and
for more
30 years 1985
2016 The College is renamed to honor the support philanthropist and alumnus Robert Larner, M.D.’42 2021 Formal launch of the Connecticut Branch Campus with Nuvance Health at Danbury and Norwalk Hospitals 1924 Dr. Dorothy Lang is the first female UVM M.D. recipient 1968 The College moves “up the hill” to the Given Building 2003 The Vermont Integrated Curriculum debuts 2020 Larner faculty, students, and staff pivot in myriad ways to pandemic restrictions Chair of Medicine Ellsworth Amidon, M.D.’32 speaks to the medical students of the Class of 1955 in Hall A, the main lecture hall of the College from 1905 to 1968. Amidon led UVM’s Department of Medicine from 1942 to 1964. 44 | UVM MAGAZINE
For students of color, the path to a UVM M.D. was even more difficult. The college first enrolled an African American medical student, Thomas James Davis, in the Class of 1885. He was followed by just 11 others over the next three decades. Today, this situation is changing, with 23% of the current Class of 2026 coming from backgrounds considered underrepresented in medicine. And in the last two decades, American society’s grad ual acceptance of varied sexuality and gender preferences has been mirrored in the college’s student body, where 19% of the most recent class identifies as LGBTQA+. Under current Dean Richard L. Page, M.D., the college has emphasized adherence to its “Statement of Professionalism” that stresses “cultural humility, kindness, and respect” as guiding principles for all members of the Larner community.
The Namesake
In 2016, the largest lifetime giving by any UVM graduate resulted in the college’s current name. Raised in the Old North End of Burlington in a family of very modest means, Robert Larner, UVM’39, M.D.’42 settled in Los Angeles after his service in World War II and built a thriving internal medicine practice while also making carefully researched and managed investments in California real estate with his wife and busi ness partner, Helen. The Larners were longtime donors to his medical alma mater, and in 2016 they capped decades of “giving back” with a
transformative gift that provided a total of $100 million to support medical education. In Septem ber 2016 the college was renamed in recognition of Dr. Larner, becoming the first medical school in the nation named for an alumnus.
Dr. Larner stated that he had one major goal with his philanthropy: “I wanted to help other medical students have the kind of stimulating, gratifying practice of medicine that I’d had,” he said.
The Larners’ support allowed the college to expand its restructuring of the medical curricu lum to emphasize active learning modes in place of static lectures. Those changes, and the educa tional technology developed to support them, also allowed the college to quickly pivot to online learning in the early days of the COVID-19 pan demic. Today, well over 90% of a medical student’s time is spent engaged in hands-on learning, in spe cial classroom facilities on campus, at clinical sites throughout the UVM Health Network, and at the college’s clinical branch campus in Danbury and Norwalk, Conn., which was established in recent years in partnership with Nuvance Health. Two centuries after four graduates were granted their medical degrees in 1823, more than 120 new UVM physicians each year go on to serve that most important person, the patient, at more than 60 institutions across the nation, including, of course, those in Vermont, where today about a third of practicing doctors began their careers of service at the academic medical center at UVM. UVM
Class of 2022 medical students are instructed in the use of point-of-care ultrasound in an active learning setting in the College’s Medical Educa tion Center. Almost all of today’s medical curriculum involves active learning instead of lectures.

FALL 2022 | 45
CONGRATULATIONS
ALUMNI AWARD
Awarded to alumni who graduated within the past 10 years who are dedicated UVM volunteers or are recognized for their outstanding contributions to their profession or life’s work.

Robinson G’12
Deputy Director, Vermont Network Against Domestic and Sexual Violence
Arealles Ortiz ’15
Entrepreneur and Owner, Curly Girl Pops
ALUMNI ACHIEVEMENT AWARD
Awarded to alumni whose exceptional achievements have been recognized at the local, state, or national level.
Chairman, President, and CEO, Massachusetts Mutual Life Insurance Company

Travis Roy Foundation

Awarded to dynamic and purposeful volunteer leaders whose loyal service to UVM has advanced the university’s mission and enhanced its reputation.





Use the camera on your phone or tablet to see the 2022 UVM award recipients’ videos.

John Hilton
Founding Director, University of Vermont Foundation



Rob Brennan ’83
University of Vermont
Carolyn Brennan ’82
Inaugural Chair, University of Vermont Honors College Board of Advisors

46 | UVM MAGAZINE DISTINGUISHED SERVICE AWARD
OUTSTANDING YOUNG
Please visit alumni.uvm.edu/awards to learn more about these extraordinary UVM graduates.
Roger Crandall
’87
’68
Lee Roy ’68
Trustee,
Trustee,
Brenda
Roy ’68 Trustee, Travis Roy Foundation
Sarah
to the winners of the 2022 UVM Alumni Association Awards
Class Notes
40Michael Eugene Paquette ’77 shares the sad news that his father Lucien D. Paquette passed away in November 2021. A brief obiturary can be found at the end of Class Notes.
Send your news to –UVM Alumni Association 61 Summit Street, Burlington, VT 05401 alumni.uvm.edu/classnotes
’47, M.D. ’50. They went on to share more than 50 years of love and devotion, four children (including Martha Ann Levine ’73), and much laughter. The family affirms that there is absolutely no truth to the rumor that Julian married Carol because she lived near Ebbets Field, home of the Brooklyn Dodgers.
Send your news to –UVM Alumni Association
61 Summit Street, Burlington, VT 05401 alumni.uvm.edu/classnotes
sad news that his dear friend Karl Greenman passed away on June 12, 2022. While at UVM, Karl played on the UVM tennis team, and he went on to serve in the Navy and have a long career in the law. He is remembered for his generosity and kind ness to others.
Send your news to –UVM Alumni Association 61 Summit Street, Burlington, VT 05401 alumni.uvm.edu/classnotes
43
Mary Beth Parker ’78 wrote to let us know that her mother Elizabeth “Betty” (Jenks) Lane passed away peacefully on July 8, 2022. After graduating from UVM’s College of Arts and Sciences, she went on to teach in Derby and Burlington, Vt. before moving to western New York. She earned a master’s degree in library science from SUNY Geneseo and became the first female faculty member of Genesee Com munity College, where she became the associate dean of the Learning Resource Center. She will be missed by her five children, a large extended fam ily, and many friends.
Send your news to –June Hoffman Dorion 16 Elmwood Dr., Rutland, VT 05701 junedorion@gmail.com
44Rose Eisman Boyarsky says she is “still here!” but has not been able to contact others from 1944 or ’45. She lives in a retirement community in Durham, N.C., and would love to be in touch with other UVMers.
Send your news to –UVM Alumni Association 61 Summit Street, Burlington, VT 05401 Alumni.uvm.edu/classnotes
46Send your news to –Harriet Bristol Saville Apt. 11, 1510 Williston Road, South Burlington, VT 05403 hattiesaville@comcast.net
47Anita Ross Pinney is still enjoying an active life Zooming with family and fulfilling many church responsibilities. Send your news to –Louise Jordan Harper 573 Northampton Street, Holyoke, MA 01040 louisejordanharper@gmail.com
49Carol Leavitt Levine passed away on January 8, 2022. Carol graduated Phi Beta Kappa from UVM, where she met her beloved husband, the late Julian Levine
51
Seth Harlow ’80 and Karen Harlow let us know that Seth’s father, Raymond G. Harlow, passed away on June 13, 2022. Raymond was a member of the UVM ski team and a long-time University supporter.
Send your news to –UVM Alumni Association 61 Summit Street, Burlington, VT 05401 alumni.uvm.edu/classnotes
55
Class Secretary Jane Morrison
53
Robert Wesley Chaffee says it’s great to have Bob Woodworth right across the hall at their Wake Robin apartment building in Shelburne, Vt. so that he and Mary Ann ’60 can see him frequently.
Send your news to –UVM Alumni Association 61 Summit Street, Burlington, VT 05401 alumni.uvm.edu/classnotes
54“Like just about everyone else,” Rob ert W. Foster hunkered down for the duration of the pandemic, with plenty of time to think about his own and shared history as a member of the UVM Class of 1954. He writes, “We came into the world only a dozen years following a once-in-a-century pandemic; we grew up during a massive depression, followed by a World War, a Korean War, another war in Vietnam and the Cold War. Now we have survived a sec ond pandemic in our lifetime and may be about to experience another European war and one more economic depression. It seems we have come full circle: What goes around, comes around, as they say.” Fortunately, Bob keeps busy with writing proj ects and with his two grandsons and three sons, reflecting, “I have tried to follow the best advice I got when I retired from my consulting engineer ing career. That is to keep busy and be occupied, whether what you produce has any value or not. Best to wake up every morning with something to do that day. As long as we keep waking up in the morning!” Bob sends greetings and “best wishes to survivors of the twentieth century with good memories of UVM.” Barry Stone ’56 shared the
Battles says that she received little news this time around and wonders, “Do you think it might be our age? Hahaha!” In any case, she hopes this finds all well, wherever you might be. She looks forward to the annual fall TriDelt reunion in Connecticut with Sandy and Bob Willey, Betsy (King) Beasley, Carol Dan, Ann and Greg Hill and anyone else who chooses to attend. Jane got to attend a graduation at UVM this past May for grandson Sam Battles ’22 (from the College of Engineering and Mathematical Sciences) and observes, “Many changes, but ever so wonder ful to be back touring campus and downtown Burl ington. Such fabulous memories! Do send me your news!” Joe Kittel ’56 wrote to let us know that Elizabeth “Beth” (Elrick) Kittel passed away May 17, 2022. The English major later returned to UVM for her master’s degree in reading instruction. The college sweethearts eventually settled in Ran dolph, Vt., when Joe became a teacher at Vermont Technical College. Beth spent her career support ing the development of readers and engaged in a long volunteer career across her community. She is remembered for her love of reading and travel, and her wonderful scrapbooks. Rumor has it that there is a piece of toilet paper stamped “property of the Queen” from Windsor Castle in one of them.
Mary Geraldine Quinn Dankowski shares that Larry Sullivan, co-executive director of the Slate Quarry Park Group, announced the Poultney, Vt., park’s grand opening on July 29.
Send your news to –Jane Morrison Battles 200 Eagle Road, Wayne, PA 19087 janebattles@yahoo.com
56
Judith (Silon) Hershberg was recently reminiscing with UVM room mate Marsha (Pearl) Jamil as both turned 87. Judith recalled the joy of living in Grasse Mount as seniors in the fall of 1955. Women were required to live in campus housing or soror ity houses all four years, and residence halls were assigned through a lottery system. With luck, the
FALL 2022 | 47 LIFE BEYOND GRADUATION
Director of Athletics Jeff Schulman '89, G’03 (left) inducts Richard Ader '63 (right) into the UVM Athletic Hall of Fame in 2017.

CATAMOUNT NATION
Holding Court
Richard Ader ’63
Richard Ader ’63 is, among other things, a philanthro pist, a successful businessman, and a tennis enthusi ast. He’s also a survivor. On a spring day in 2019, he lay in a medically induced coma, fighting for his life. Days before, the lifelong athlete had collapsed on the tennis court mid-match due to a condition called atrial fibril lation—his heart was out of sync and failing. After two days, he woke up in a hospital room, completely incapacitated and surrounded by family.
“I thought I was dead,” says Ader. “I kept asking for proof that I was alive. I saw Notre Dame Cathedral in flames on the television screen and thought that couldn’t be real.”
Over the course of the next year, Ader fought assid uously to regain strength and muscle mass, to return to everyday activities like walking, working, and even playing tennis. Following a second incident, he made the difficult decision to undergo a procedure to equip him with a Left Ventricular Assist Device (LVAD), a machine that would save him from certain death but potentially alter his capacity to live fully. Facing what may have been game, set, match for most, Ader
two were able to choose Grasse Mount, the beau tiful historic building that now houses the UVM Foundation. At the time it was a special residence for senior women only, and they jumped at the chance to live there. Marsha in turn shares a rec ollection she calls, How Relevant Are Manners? “It was 1954, I was a sophomore. Miss Wing, assistant to Dean of Women Mary Jean Simpson, called me into her Redstone Campus apartment. My room mate Judy and I had been up all night studying for an exam. Before leaving the dorm for break fast at Valades (a long-gone restaurant once in downtown Burlington), I lacquered my nails with green nail polish. I don’t know where one found green nail polish in those days. Miss Wing glared, ‘It’s bad enough you left campus and broke curfew,’ (I didn't know we had a morning curfew; week nights for freshmen was 8:30 p.m. and for sopho mores, 9:30 p.m.) ‘but green nail polish?!’ My pun ishment was the removal of my name from a list of candidates for Mortar Board, a club of leadership women. Oh well, I was against being selected for special treatment anyway. Wonder what she would she say about two daughters and one daughter-inlaw showing up for dinner wearing ‘marshmallow,’ ‘baby blue,’ and even ‘black noir’ nails?”
Send your news to—
Jane K. Stickney
32 Hickory Hill Road, Williston, VT 05495 stickneyjane@gmail.com
57
June Sherwin and husband Phil live in Arlington, Vt. She enjoyed teaching home economics for 21 years, first in Connecticut and then in Missouri. They volunteer at their church and for a program titled Neighbor to Neighbor, spend some of the winter months in Long Boat Key, Fla. and love being great-grandparents. Send your news to –UVM Alumni Association
61 Summit Street, Burlington, VT 05401 alumni.uvm.edu/classnotes
58
Louis Kiefer is pleased to announce the publication of his book "The Fuzzy Pink Bathrobe & Stories of Law," available on Amazon. It’s about absurd, unusual, and funny stories from the practice of law. Stu J. Zeitzer says he’s “still hitting them pretty fair” play ing 2-3 rounds of golf a week, and that he and Susie are enjoying togetherness with old and new friends.
Send your news to –UVM Alumni Association
61 Summit Street, Burlington, VT 05401 alumni.uvm.edu/classnotes
59
Send your news to –Henry Shaw, Jr.
7503 Still Hopes Drive, West Columbia, SC 29269
60
Serene Meshel-Dillman ’85 has written to let us know that her dad Robert Meshel passed away March 30 at his home in Mill Valley, Calif. By his own words, he lived a charmed life. He met his wife, Miriam (Reiner) Meshel, while at UVM and the two were married for 58 years. After a diagno sis of a rare cancer, Miriam chose to end her life in 2017. Robert made the same choice after receiving a diagnosis of non-Hodgkins lymphoma. Serene's documentary film project outfeetfirst.com is an homage to the two of them. Alumna of the College of Nursing Susan Sprigg has passed away. She was known and admired for a decades-long nurs ing career, and for the love and infectious laughter that she shared with her family and her husband Gordon Sprigg.
Send your news to –UVM Alumni Association
61 Summit Street, Burlington, VT 05401 alumni.uvm.edu/classnotes
61Bob Murphy reports that both he and his wife, Lynda, recently contracted COVID but have recovered and are doing fine. He recently attended the 65th reunion of Wells River, Vt., High School and notes that six of the nine in his 1957 graduating class went to UVM and five of them graduated together in 1961: Walt Bone, Harriet Pudvah, Ann Sherwin, Ama lia Homeister, and Bob himself. Roger Zim
48 | UVM MAGAZINE
endured. Through sheer personal will and the help of his network of family, friends, and health care providers, he started from square one to rebuild himself for a second time.
In his new book, “How to Rally: Wisdom from a Life Spent Beating the Odds”, Ader details his remarkable recovery from the two near-fatal cardiac events and imparts his own wisdom for overcoming obstacles and persevering in the face of great adver sity. Through anecdotes from the past, he weaves a powerful story that reveals an innate competitiveness, dogged determina tion, and zeal for life.
After losing his father at age 15 and enduring the resulting financial strain on the family, Ader strove to reclaim the secu rity and financial stability he had known as a child. He pushed himself to excel.
“I entered adulthood understanding that nothing is guaranteed. I wanted to be the best and had the confidence that I could succeed at anything I set my mind to. That ambition has driven me throughout my life.”
A gifted athlete, he trained relentlessly in high school to earn a basketball scholarship to UVM, his ticket to a degree in banking and finance—and to a successful future. Ader became a pioneer in the corporate real estate
net lease industry and founded U.S. Realty Advisors, LLC in 1989. He discovered a love for tennis in his 30s and has since served in various capacities to bring others into the sport. A strong advocate for youth tennis, and especially its ability to empower underserved children, he established a chapter of the National Junior Tennis Learning Network in Bennington, Vt., expanding the program into a rural area for the first time. He has provided decades of support and leadership to many service organizations he believes can make a difference, including Southwestern Vermont Health Care and the Women’s Sports Founda tion, among others. And he has not forgotten his alma mater.
“UVM was a very important part of my life. The basketball scholarship and the education I received put me on the path to a life that I could never have dreamed of back then. UVM took a chance on me when no one else did, and I’ve always felt that I should give back.”
Ader and his wife, Pamela, have been longtime supporters of initiatives across campus. Most notably, they have endowed a Green & Gold Professorship, established an endowment in Holocaust Studies, and made lead gifts in support of Billings Library, UVM
Alumni House, and the Athletics Facility Project. Richard serves as chair of the College of Arts & Sciences Board of Advisors, and he has served as a member of the UVM Founda tion Board of Directors. He is an active mem ber of the Foundation Leadership Council and the Foundation Finance & Investment Committee. He was instrumental in bringing his friend and occasional practice partner, tennis legend Billie Jean King, to UVM as Commencement speaker in 2011.
Ader was inducted into the UVM Athlet ics Hall of Fame in 2017. Today, against all odds, he says he is moving on the court bet ter than he could have ever imagined. LVAD strapped securely at his side, he has perfected his two-handed back stroke. He is still push ing himself, still making plans to do more.
“I have work left undone. I have rela tionships I care about and people I love and want to keep getting to spend time with. I have deals I want to do, and business I want to win. I have tennis matches to play, grand kids to enjoy, causes to champion, and peo ple to help.”
Go to go.uvm.edu/richardader to hear Ader speak about his book, “How to Rally: Wis dom from a Life Spent Beating the Odds.”
merman checked in as he was getting ready for a 20k bike race in the Maine Senior Games. It’s a qualifier for the Nationals next year. He had already qualified in the 400- and 800- meter track events.
His last backcountry ski guide work in Yellowstone was just before COVID took off, and he reflects that “that may be it,” especially given the recent catastrophic floods there. He says that daugh ter Heather is in South Africa on a special project and will return shortly for her last year at Yale Law School. He sends regards to all. Send your news to –
Steve Berry
8 Oakmount Circle, Lexington, MA 02420 steveberrydhs@gmail.com
62Lawrence F. Simon is still active as a surgeon at Montefiore Nyack Hospi tal. Richard Thomas Aldinger let us know that he and Theta Chi fraternity brother Tom Sherman and wives Janet and Anne recently com pleted a 10-day trip through the Canadian Rockies from Calgary to Vancouver including stops in Banff, Lake Louise, and two days on the Rocky Mountain eer train. Jules Older thinks he might have found a solution to excessive night-time urination and has published an article in the journal New Zealand Doc tor (readable online). He says this is his first publica tion in a medical journal since 1988 and it’s called, “Nocturia, Take Three – To Pee or Not to Pee.” Barry D. Marcus has retired after 45 years of practicing
law and now spends much of his time in Vermont. His wife Sue (Milman) Marcus ’64 passed, and Barry is now remarried to Lynne, who performs regularly at the Dorset Playhouse. Forrest Woody Manning has signed up for another year of substitute teach ing and student support at Middlebury Union High School. At 83, he is the on-call substitute teacher and still looks forward to going to work “each and every day.” Edward Freedman is living happily in Green Valley, Ariz., engaged in birding, photography, and volunteering. He notes with interest the number of UVM and Vermont folks there. He wishes all fellow octogenarians well. Patricia Ellen Gitt has pub lished her latest novel, her sixth about accomplished women facing a crisis and their journey to resolution. See more at her website: patriciagitt.com. Send your news to –Patricia Hoskiewicz Allen 14 Stony Brook Drive, Rexford, NY 12148
the Hon. Lawrence P. Cohen, died in Decem ber 2021. After graduating from UVM, Larry went on to a long and illustrious legal career in Massa chusetts. Larry is also survived by his sons, Jeffrey P. Cohen ’90 and Timothy M. Cohen ’91, and his daughter, Jill (Cohen) Gent ’96, who is mar ried to Richard W. Gent ’96, as well as 10 grand children, a brother, and a sister. Allen T. Jenkins still lives in the house from which he left to attend UVM. He approaches 50 years of being married to a Colby alumna, has two married boys (men now) with three grandchildren. Though a hip replace ment forced him to give up skiing, he still goes to the gym and plays golf (with a cart). And on top of that, he paints with watercolors and has been studying Italian for the past three years.
Send your news to –UVM Alumni Association
61 Summit Street, Burlington, VT 05401 alumni.uvm.edu/classnotes
63
As Frank A. Bolden approached the 10th hole of a recent golf out ing for Union County College (on whose board he served for a number of years), the golf pro looked at his hat and asked if he went to UVM. “Guilty,” replied Frank, “in the last century.” The pro said that he did too, and turned out to be Wally Kim ’90. The two were not only both UVM alumni, but both from the same town. “Small world,” observes Frank. Carol (Murray) Cohen ’64 sadly reported that her husband of 58 years,
64
Class Secretary Susan Griesen
beck Barber sends greetings to all from the shores of Lake Champlain where she summers every year, and where she and Linda Sparks got to visit recently. She wishes all health and happiness.
Send your news to— Susan Barber
1 Oak Hill Road, Harvard, MA 01451 suebarbersue@gmail.com
FALL 2022 | 49
65
Samuel “Sandy” Flaster, M.D. caught his biggest muskie to date: 46 inches, 27 pounds. He says he’s a “mediocre golfer with three holes-in-one and plays 6 times a week. Chicago in the summer and Mizner Country Club in Delray Beach, Fla. in the winter. Mar ried 53 years to Nancy with two children and three wonderful grandchildren.” Regina (Robicheau) Ralston and her husband, Walter, moved back to her home state of Massachusetts after 40 years liv ing in the desert of Arizona. They love living on Cape Cod and bought a house owned by her grandpar ents in the 1930s. She and Walter met in junior high in Quincy, Mass., and reconnected on Facebook in 2010, which they call “a surprise even at this time in their lives.” After 33 years with Pfizer, Eugene Martin Weiss retired in 2010. He lives in New York City with his wife of 46 years, Susan, his two daugh ters, and four grandchildren. He was sorry to learn of the passing of Wallace Leifer ’66, a very good friend whom he had lost contact with for over 40 years, and has rekindled his friendships with Alfred Secunda ’66 and Roy Zuckerman ’67. Send your news to –UVM Alumni Association 61 Summit Street, Burlington, VT 05401 alumni.uvm.edu/classnotes
ects, though “COVID has put the brakes on travel for awhile.”
67
Mark Oliver, M.D. died on May 16 after a short battle with Creutzfeldt-Ja cobs Disease. He earned his under graduate degree in mathematics from UVM and was a member of Alpha Epsilon Pi. He went on to earn his M.D. at Chicago Medical School and was a beloved family doctor up until his death. Ellen Joan Werner is thrilled to report her grandson, Louis Walker, is entering UVM’s Grossman School of Business this fall; he is the 10th Werner to attend UVM. It all started with Harry Werner ’37, M.D.’41 and Anne Cohn Werner ’42. Donna Baraw Wheeler says she is “loving life in Stowe, and especially time with granddaughters!” Send your news to –UVM Alumni Association 61 Summit Street, Burlington, VT 05401 alumni.uvm.edu/classnotes
Send your news to –Mary Moninger-Ella
1 Templeton Street, West Haven, CT 06516
70Send your news to –Douglas Arnold 11608 Quail Village Way, Naples, FL 34119 darnold@arnold-co.com
71
Class Secretary Sarah Wilbur
66
Class Secretary Kathleen Nunan McGuckin writes, “Since moving from St. Augustine, Fla., in Septem ber 2021 to Prescott, Ariz., my husband, Ken McGu ckin, and I have hosted UVM 1966 classmates and good friends at our home. Those who visited us are Nancy (Castellanos) Miller and her husband, Chris; Anne (Appleton) Weller; and Carol Nei man Spatz and her husband, Dean. The ladies and I are all proud members of Kappa Alpha Theta. What enjoyable times together. May they continue.” Carol Jenne Jones and her husband, Peter, have been living in Western Australia for just over a year and have seen the nation go through a major gov ernmental shift in an election cycle that lasted only six weeks. She reports, “We are as happy as can be in our coastal town (small city) on the Indian Ocean with lots of family all around us.” Warren I. Kaplan and his wife, Julie, now both fully retired, have moved to the Bellaggio community in Lake Worth, Fla., and say they would love to hear from any UVMer neighbors. With sorrow, friends and family have shared the passing of College of Engi neering and Mathematical Sciences alum Wallace Leifer. “Waldo,” is remembered as an unwaveringly loyal and dedicated husband, father, uncle, in-law, and friend who had an immeasurable effect on many, many people. The “proud Brooklynite” went on to a become a member of the engineering team for Apollo 11 NASA astronauts Neil Armstrong and Buzz Aldrin. He is survived by his wife and daugh ter and a large extended family. Donald E. Saw yer wrote over the summer to let us know that he and Rebecca Laskin will be married on November 5, 2022, and that “both are on cloud nine!”
Send your news to –Kathleen Nunan McGuckin
416 San Nicolas Way, St. Augustine, FL 32080
68
Class Secretary Diane D. Glew shares that Jack Rosenberg received the Moderator Award from Viewbug in recognition of continuing to find inspi ration to take and share photos despite challeng ing times. He also received the Halfway22 Award for his picture “You’ve Got Me All Twisted and Tied Up,” recognizing his sharing, creativity, and ways of connecting with people. Diane offers enthusiastic congratulations to him. Georgia Walsh Miller and husband Richard Miller have moved from Connecticut to Falmouth, Mass. They’re enjoy ing ther retirement and say, “Come visit!” William M. Young writes, “In the past year Sally (Ser rell) Young ’70 and I sold our Burlington house of 30 years and bought houses in Cabot, Vt. and on Lake Mayo, Roxboro, N.C. We are able to work with our flat-coated retrievers each day, are active in a variety of work and interests, and are reasonably healthy for a couple of old duffers!”
Send your news to –Diane Duley Glew Unit 2, 23 Franklin Street, Westerly, RI 02891
69
James Betts, ’69, M.D.’73 shares, “It’s Memorial Day weekend as I write to everyone. I’m still in pediatric sur gical practice and serving as a firefighter with the Big Sur Fire Department on my weekends off call. I’m looking forward to being on campus this fall. Much to celebrate, and yet to be concerned. At my pediatric trauma center, we receive many children who have been wounded by gunfire. In the tragic wake of the horrific murder of those children and adults in Texas, I urge us all to work toward bet ter gun control. My fiftieth College of Medicine reunion will be in ’23. Seemingly so quickly have the decades passed. Stay well Classes of ’69, and COM ’73.” After 50 years of working for the Vermont Agency of Transportation, Richard David Hosk ing has “retired—sort of.” He was approached by Vermont Emergency Management to work parttime to assist towns that have storm damage that involves federal emergency assistance. He says that he still has plenty of time for his own proj
Sprayregen writes, “Our 51st Reunion weekend seems ages ago, but still brings back fond memories of June 10-12. I want to thank the entire Reunion Committee for all of their ideas and energy getting so many classmates to return to campus for this milestone. We wish more folks could have attended, but those who did had a won derful time. There were timely lectures with current faculty, and the tour of Cohen Hall—with Michele (Resnick) Cohen ’72!—where we learned about the vitality of UVM’s arts programs was a highlight! I had wonderful conversations with Dan Hober man, Milo Shelly (all the way from California!), Deborah (Wright) Boule and Richard Boule G’76, and Marcia McKenzie from Montreal who was attending her very first reunion! It’s always great to see my neighbor, Bruce Cassler, Cyn thia (French) Pasackow who had a long teaching career at Champlain Valley Union High School (in Hinesburg, Vermont), and Rob Sydney Pat Vana is a regular at each of our reunions and it was fun to learn that she’s missing out on her curling in Ver mont, but enjoying several outdoor sports in Flor ida during the winter! It is always great to see Chris (Warden) Malley and Ed (they are always the life of the party), and the best thing was seeing Owen Jenkins at most events looking great with Wendy (Reilly) Jenkins ’73 G’86. As a post script, since Joanne (Czachor) Magliozzi and Mags (Caney) Conant couldn’t make the Reunion, we hatched a plan to have our own mini-reunion in late July when Joanne could travel to Burlington. Liz (Mead) Fos ter joined us for an outing to see the Soda Plant (developed by Mags’s husband Steve Conant ’78), which was fascinating, and have lunch on the Burl ington dock following. It made me realize that most things don’t change—like no shortage of conversa tion! I missed Myron Grauer and Jason Robards, but hope to see them before too long! The week end wasn’t the same without them! Please stay in touch.” Stuart “Tim” Scott writes to let classmates know that he moved to Florida 12 years ago, was married for 22 years, then divorced, but raised two wonderful children. He remembers Vermont’s beau tiful country and the hijinks he had 50-plus years ago, observing that “college is not the lark it was when we were there.” His son has two daughters, and his daughter is a manager at a large legal ser vices firm in New York City. In his career, Tim worked in the large commercial insurance industry, and for IBM, AIG, and Wells Fargo before ending his work ing life as an analyst for the U.S. Government in Jack sonville, Fla. Since retiring in 2017, he has been writ
50 | UVM MAGAZINE
kkmcguckin@comcast.net
| CLASS NOTES
ing; his first book was published in May 2022, titled "Driving Toward Destiny." It’s a novel about a 4,000km motorcycle trip he took through eastern Europe in 1972 while waiting to hear from the draft board.

Robert Rogers Hawes writes, “After graduation, I interned and taught in an alternative program at Lake Region Union High School (in Barton, Vermont) for five years. Married classmate Barbara Jerry, in May 1975. Two daughters, Heather and Jillian ’03. Worked on an offshore lobster and swordfish boat, for Bank of New England, the seafood industry, and in financial services for business owners. Barbara battled bravely in the midst of the pandemic, but said good-bye to her family and was lifted to God’s embrace in 2020.” Christine Mosher Labone retired a few years back and is enjoying trips around the northwest of Western Australia, where she says there’s so much to see and discover. Marc Stephen Milowsky writes that it was great seeing everyone at the June class reunion and sends thanks to all for the hard work to make it happen. He also notes hap pily that their daughter Maddy is expecting his 12th grandchild in December 2022.
Send your news to –Sarah Wilbur Sprayregen 145 Cliff Street, Burlington, VT 05401 sarah.sprayregen@uvm.edu

72
Class Secretary Debbie Stern writes, “Our class had a wonderful 50th Golden Reunion celebration with the classes of ’70 and ’71 in June. The campus never looked more beautiful. The weather cooperated and it was a lovely summer weekend in Vermont. It was nice to see my AEPhi sorority sister Debbie Lewin Kull, as well as friends from ADPi, Nancy (Tabke) Ooms, Michele (Resnick) Cohen, Sally (Streeter) Zoppo, Ellen Halsted, Sally Watts, Anne (Bennet) Snyder. It was also nice to catch up with Kathy Mackin, Margo (Witten) Johnson, Jennifer Oakes, Barbara (Crandall) Cochran, Ed and Jane Krasnow, and Jim Keller to name just a few. Some of the reunion activities included a tour of main campus, plus the new Fires tone Medical Research Building and the Michele and Martin Cohen Hall for the Integrative Creative Arts. (Make sure to see the pictures on the UVM web site!) Debbie Lewin Kull has established a schol arship in memory of her husband, Lawrence Kull
It was at UVM where Larry met Debbie, the love of his life. Larry was a mensch, guided by his principles, work ethic, and warm heart. Larry will be remem bered fondly by all who knew him for his kind and generous spirit. He was an eternal optimist with a big bright personality. He loved golf, birding, kara oke, summers down the shore and winters in Flor ida. Larry cared deeply and had much love for his children and grandchildren. Debbie established the scholarship to memorialize Larry and to encourage other athletes from New Jersey to achieve their aca demic and athletic goals at UVM. The Lawrence Kull Memorial Scholarship will be awarded to two ath letes each year.” Deborah (Smith) Bedrin offers,
“Thanks to all involved for an amazing 50th Reunion. It was so fun to connect with classmates, and the meals, etc. were fantastic.” Lawrence S. Clark is “sorry to have missed the 50th!” After graduation he served six years active duty as an Army M.P. officer, three in Virginia and three in Germany. Once home, he earned a M.Ed. in counseling and then spent 30 years in Bellows Falls, Vt., schools before retiring. His current activities include work with the local fire department, the historical society, state-wide critical incident stress management team, and serving as a Vermont fire services instructor. He observes, “That 50 years certainly went by fast!” Karen L. Morris notes that she “so enjoyed the 50th Reunion—so fun to re-connect with many classmates! Kudos to UVM for great hospitality. All good with me. I am not a retiree. Still working as an elected judge and col lege professor. My judicial term ends in December 2023 and I will not run for re-election. I still enjoy teaching and will continue for a bit more. Here’s wishing everyone well!” Patty Q. Thomas offers to solve a mystery: “If you have atttended UVM men’s hockey games, you may have wondered who holds the VERMONT banner behind the glass at the team’s first warm-up. It’s me! I have been with the Cats for 53 seasons, though not all of them with the ban ner. That banner is over 100 years old and belonged to Frederica B. Northrop. She attended UVM from 1919-1921. My cousin found it on eBay and gave it to me in 2005—without any idea that Frederica's cousin had married our cousin in 1960!”
Send your news to –Debbie Koslow Stern
198 Bluebird Drive, Colchester, VT 05446 Debbie2907@gmail.com
2023 UVM Discovery
READ CLASS NOTES ONLINE alumni.uvm.edu/notes Use the camera on your phone or tablet to see our
Travel trips. You can also visit alumni. uvm.edu/travel Where should we go next? The Alhambra, Granada, Spain
73
Golden 50th Reunion Celebration


June 9-11, 2023
Class Secretary Deborah Mesce says that Alan “Ace” Bugbee has offered a trivia question: “Rela tive to the UVM Class of ’73, what do the Edgar Win ter Group’s "Frankenstein" and the Rolling Stones’ "Honky Tonk Women" have in common?" Deborah says, “I don’t know the answer, but send me your suggestions and I’ll forward them to Ace to report the winners in the next issue of the magazine. And who knows? We may even have a prize by then.” Karen Blakney sends greetings to all and muses, “Can you believe it has been almost 50 years since graduation?” After “hopping around the coun try” a bit, she reports she’s now settled in glorious Utah. Artist and sculptor Chris Curtis completed a 1,500-mile “pop-up” sculpture tour with his 24-foothigh by 21-foot-wide sculpture titled “That Place In the Stars” in spring 2022. Launching from the Trapp Family Lodge in his hometown of Stowe, Vt., Cur tis transported his sculpture to Pratt College of Art & Design (Utica, N.Y.), The Public Market (Rochester, N.Y), University Circle (Cleveland, Ohio), Cincinnati Observatory (Cincinnati, Ohio), Malcom W. Martin Memorial Park (St. Louis, Mo.), and concluded with an exhibit at the Philbrook Museum (Tulsa, Okla.). The tour took four weeks, after which the sculpture was installed at the home of a patron in Tulsa. Bar clay Morris of Grand Isle, Vt., writes that his wife of 42 years, Ellen Sabo Morris, member of Alpha Chi Omega while at UVM, passed away in Novem ber 2021 after a valiant 20-month battle with endo metrial cancer. Albert Gardner Thayer went to Wiesbaden, Germany in June. He visited his son in
the U.S. Army and attended the high school gradu ation of granddaughter Kathryn Thayer. Send your news to –UVM Alumni Association


61 Summit Street, Burlington, VT 05401 alumni.uvm.edu/classnotes
74
Jane Robin Bradbury and her hus band, Ernest Norris, are enjoying their move into the upstate New York home where she grew up. She is semi-retired, working as an arts marketing consultant on projects that inter est her in the performing and visual arts, along with serving on the board of a small historic theatre. They are enjoying time with their two daughters and their spouses, along with two young grand children, and say, “Life is good!” Paul F. Kenny sold his Sun Valley, Idaho, franchise, Engel & Volk ers Luxury Residential Real Estate firm, to the Engel & Volkers Gestalt Group of Park City, Utah. Paul con tinues to operate Paul Kenny & Matt Bogue Com mercial Real Estate in Sun Valley. Sharon Malo ney Newton writes, “I’m enjoying the retired life after working in variety of nursing positions from management to ICU, home care, and eventually in a maternity unit. I’m so grateful that working as a nurse gave me so much flexibility to match my work to my lifestyle as life circumstances changed. Every position was in its own way exhausting and yet always rewarding. To celebrate my retirement, I took a UVM alumni trip to Africa and just returned from visiting Scandinavia with Viking. I still love music (still singing), reading, cooking, tennis, and am just taking up golf. I live in the San Francisco Bay Area with my husband and have twin sons, one
living nearby and one in Colorado. I frequently visit my mom in Pittsburgh and my in-laws in New Jer sey, and hope to make it our 50th reunion in 2024. Any chance to connect and hear from you would be wonderful, I have such great memories of our years together now so long ago!” After teaching for 48 years, Linda Rough Probst retired as lecturer emerita at the University of North Carolina at Char lotte in June 2022. For 37 years she was the grad uate teaching assistant supervisor and mentor in the Department of Kinesiology, Exercise Science Program. She was also the Lifetime Fitness Activity course coordinator and taught many courses. She and her husband bought an RV and two motorcy cles, plan “glamping” trips and time with children and grandchildren in Boston. They look forward to making some trips to Vermont. Send your news to –Emily Schnaper Manders 104 Walnut Street, Framingham, MA 01702 esmanders@gmail.com
75
Joe Choquette found a great retire ment job at the Country Club of Barre (Vermont) where he manages mem berships and works a couple of mornings a week in the pro shop. He is eager to welcome all UVMers past and present and hopes you will say hello when you show up for your tee time!
52 | UVM MAGAZINE | CLASS NOTES| CLASS NOTES
Class of 1973, we’re getting ready for you! Let us know you’re coming at alumni.uvm.edu/1973reunion Classes of 1970, 1971, and 1972— thanks for the memories! We’re glad you had so much fun at your 50th Golden Reunion last June. Save the date. Reconnect. Rediscover. JUNE 9-11, 2023 MAIL YOUR CLASS NOTES: UVM Alumni Association 61 Summit Street, Burlington, VT 05401 SUBMIT YOUR CLASS NOTES: alumni.uvm.edu/notes
26261
34134
76Andrea Kalisch Casey says that exploring Thailand and Indonesia with their son and his wife has given them a new perspective of the world. Cameron Anne Davis writes to say, “I have retired after teaching 34 years with the UVM Department of Art & Art His tory. It has been a joy and honor to work with our students. I will miss them terribly! You will find me in my studio painting and working on several col laborations, including the creation of a stage set for composer Sam Guarnaccia’s Emergent Universe Oratorio to be performed by Albany ProMusica in 2024. Stay tuned! camerondavisstudio.com.” Mar garet S. Hilly writes, “I have been trying to keep up with my 94-year-old mother, Marilyn. She has dementia but still skis, dances, swims, and sings! I have also been judging dressage schooling shows, teaching riding in Vermont’s Mad River Valley in the summer, and skiing in the winter. I intend to get back to my art, but it’s been such a nice sum mer to be working outside... Make hay while the sun shines! My fiftieth high school reunion is this fall.” Donna M. Laurin continues to work as a social worker for her local visiting nurse and hos pice agency and as a home-based mental health clinician in her local community mental health agency’s elder-care program. She loves visiting clients in their own homes and still lives in Ver mont’s beautiful Northeast Kingdom. Heather Anne Logan shares, “After a career in education, most spent in Utah, I have returned to Harpswell, Maine and started a new career as the director of the Cundy’s Harbor Library. Known as a little library with a big view, it sits on a working waterfront har bor. Come picnic, sit on the deck, and visit when you are coming to Vacationland!” Catherine Bur dick Mattheis tells us, “My family is coming full circle back to Vermont. I’m in the process of build ing a home on land that has been in my family for generations. Delighted to discover the builder and the architect I’m working with both have UVM ties (many years later!!). Retired now from a career in education in which I had the opportunity to teach in Tunisia, Belgium, Texas, and most recently, Con necticut, I turn to Vermont to nurture me and my family, including my three children and four grand children. Looking forward to being a Vermonter once again!” Paul Paco Prior is still drumming daily. He, “successfully dodged the COVID bullet, and is enjoying retirement and living the ‘lake life’ in northwestern New Jersey.”
your news to –
Paul Beekman
2 Elm Street, Canton, NY 13617
David Orman Cote retired in 2021 following a career as a U.S. Army Medi cal Service officer, as director of opera tions for Kaiser Permanente, a public health execu
tive at the state and national level, and a consulting manager with Booz Allen Hamilton. He currently lives in Fairfax, Va., but is looking forward to mov ing to a more relaxed area with less traffic! Mary Pryor Heller reports that Kristy McLeod and Polly Whitmore traveled west to meet up with her in St. George, Utah, for a college roommate reunion. Abby Mandel continues to teach parttime in the Physical Therapist Assistant Program at Northern Virginia Community College. She is lov ing being a grandma and is expecting her sixth grandchild in January. Bernd “Ben” Mattheis and Catherine (Burdick) Mattheis ’76 grate fully celebrated their 50th wedding anniversary on February 2, 2022. The Alaska-to-Virginia event was hosted as a “Zoom-ebration” by their children, Alli son, Erik, and Geoffrey, and attended by family and longtime friends all supporting the theme “longterm marriage is not for sissies!” Their family wel comes their fourth grandchild, Cedrus Aster Mat theis-Wong, born in East Los Angeles in April. They were also pleasantly surprised to learn one of their recently arrived neighbors, Catherine (Cronin) Coleman ’70, is a fellow Catamount! Charles Frederick McMaster has been elected to the Board of Directors of the Texas Beekeepers Associ ation, representing Texas Beekeepers in the areas of animal husbandry, property management, and business management matters. He is also a senior staff member at Hives for Heroes, a nationwide vet erans support organization matching aspiring vet erans and first responders with beekeeping men tors in their communities, providing them with “purpose, focus, and mindfulness.” Lesléa New man’s newest children's book, "Alicia and the Hur ricane: A Story of Puerto Rico/Alicia y el huracán: Un cuento de Puerto Rico," was published by Lee & Low Books. Every night Alicia falls asleep to the soothing song of her beloved coquís (tree frogs) native to her homeland. When a hurricane devas tates the island, the frogs grow silent. Will Alicia ever hear their song again? William Rowland offers a PSA (public service announcement) about your PSA (prostate specific antigen): “Last summer, my PSA reached 4.2. I did not worry because I felt that a PSA of about 4 was OK for someone my age. A friend encouraged me to look into this further, so I had additional testing done. It turned out I had a high Gleason score and relatively serious pros tate cancer, which was promptly treated before it spread outside the prostate. So just a warning to take your PSA tests regularly and pay attention!” Doug Shealy reports he now does dentistry just three days a week and has time to attend local classic car shows with his ’66 Sunbeam Alpine and ’63 Ford Futura convertibles. He says “hi” to Kevin, Bruce, and Lori. Kathleen (Brown) Sorkin sends news from Leesburg, Va., and loves it there. “I am enjoying being a grandma to two boys and two girls with another grandson due in August. I had a wonderful family reunion in July with my three daughters and their families. I wish everyone a great year.” Lisa (Ringey) Ventriss retired on June 30, 2022 after serving one year as the interim dean of the Stiller School of Business at Champlain College, right on the heels of her 2021 retirement
after 19 years as president of the Vermont Busi ness Roundtable. She says it’s now time to play with her grandchildren! We send good thoughts to Rob Martin Waxman, for whom “it’s been a rough year. Sarcoma in my right calf returned after 11 years. Nothing could be done but below-theknee amputation. I’m waiting for the time when I can get a prosthetic and can walk and drive again. I’m also going to push to get a prosthetic I can play tennis with. I’m still teaching part-time and playing music.”
Send your news to –UVM Alumni Association 61 Summit Street, Burlington, VT 05401 alumni.uvm.edu/classnotes
78
Judy Currier informs us with deepest regret that College of Agriculture and Life Sciences alum Geoffrey A. Cur rier passed away on December 15, 2021 of kid ney failure. She says that Geoff worked right up to the end, doing what he loved: running his upperend landscaping business. He leaves his son, Sam, his two sisters and two brothers and six nieces and nephews. Barbara Lynn Sean Donahue received her 12th Emmy, for live sports coverage of the Los Angeles Kings, and says it’s a privilege to get to work with them. Geoff M. Greig is living in Fernie, Brit ish Columbia, and really enjoying the skiing, hik ing, and town. Eileen Gertrude Cammilla Kris tiansen writes, “I earned my EdD on May 21, 2022. This was 11 years to the day after earning my MEd on May 21, 2011, both from UVM. These degrees are in addition to a BS in education in 1978 from UVM and a BS in accounting from Trinity College in 1997. I retired from UVM on March 31, 2021 after more than 26 years of service.” Jeffrey Alan Stearns and his daughter Alexis traveled from Chandler, Ariz., to tour UVM in July. He says that UVM is high on her list of desired colleges and universities when she gradu ates high school in 2024.
your news to –UVM Alumni Association 61 Summit Street, Burlington, VT 05401 alumni.uvm.edu/classnotes
79
Teressa Marie Valla says it’s an honor to have her digital image Dance the Night Away in the permanent col lection of the Museo del Desierto, Saltillo, Mexico. It was included in the recent exhibition The Desert through the Eyes of New York’s Female Creators. She notes that the museum is one of the most comprehensive natural history museums in all of Latin America.
80
Maureen Lynne McLaughlin says, “What a treat it was to have Jan (Crawford) Hennessy ’81, David Hennessy ’81, David Fay ’81, Brenda Burn ham ’82, Matthew Beck, Gretchen (Gannon) Paulsen ’83, and Marshall Paulsen ’82 with us here in Orleans on Cape Cod.” Kim (Watts) Nicksa
FALL 2022 | 53 Send your news to –Dina Dwyer Child Unit 102,
Devonshire Court, Bonita Springs, FL
dchild@aol.com
Send
pbeekman19@gmail.com 77
Send
Send your news to –Beth Gamache bethgamache@burlingtontelecom.net
NOTES
gathered on the lake in Highgate Springs, Vt., with Jan (Waterman) Cohen, Mary Jarrett, Nancy Lee Monroe, Allison Fraser, Pam (Rogal) Zlota ’81, Bonnie Caldwell ’81, and Betsy (Faunce) Andrews ’81 to attend the 100th anniversary of Alpha Chi Omega, and it was “so much fun!” Carol (Specht) Polakowski writes to share news from her career and her home life. After she graduated from UVM, she worked as a programmer with IBM, followed by a second career at their financial advi sor’s office before retiring in 2019. In 2020, she and husband Chris fulfilled their dream of building a retirement home near where her family’s beach house had been in Bethany Beach, Del. Chris retired in 2021 after 42 years of teaching middle school physical education, and now the two are full-time residents of Ocean View, Del. She says, “I loved UVM and living and working in Vermont, but now I’m so happy to be back in old familiar territory and close to the ocean.” Susan (Johl) Potter writes that Pete Potter ’79 retired from Delta Air Lines In March 2022. As a 767-400 captain flying mainly interna tional routes, his distinguished career ended with a final flight to Frankfurt, Germany with friends and family onboard. Pete’s aircraft received a water can non salute as he taxied to the gate, and Susan fol lowed that with a retirement party at the JFK’s TWA hotel. The couple has been married for 41 years and will continue to travel, enjoy a new grandson, and spend time catching up with Air Force and airline friends all over the country. But they say they “still love the bike trails and great beer selection in Ver mont!” Michelle Ducharme Rocheleau writes, “Never in a million years when we were in Flor ida laying on the beach during spring break in 1979 and 1980 did we ever think that some
day all of us would have homes in Florida and be starting the next chapter of our lives. We have been best friends for more than 40 years now since those days at UVM on Wing 3rd. We’ve been through thick and thin, lived thou sands of miles apart, but always remained just a phone call away. We are always so happy to see one another, laugh, and appreciate the lifelong friendship of Kathy Kearney, Janet Feldman, Sue Souther, and former Student Association president Dale Rocheleau.”
Send your news to –UVM Alumni Association
61 Summit Street, Burlington, VT 05401 alumni.uvm.edu/classnotes
81
Send your news to –UVM Alumni Association

61 Summit Street, Burlington, VT 05401 alumni.uvm.edu/classnotes
ter, joy and love. Thanks for the memories. You will be greatly missed.”
Send your news to –John Peter Scambos pteron@verizon.net
83Jim Donnelly and Cathy (Blouin) Donnelly ’84 have relocated from Mansfield, Mass., to Hendersonville, N.C. They are looking forward to adventures in the Blue Ridge Mountains but “will never forget the Green.”
Send your news to –Lisa Greenwood Crozier lcrozier@triad.rr.com
Honoring
Two of UVM’s Brightest Stars
Daniel ’55, HON’08 and Carole Burack HON’08 are the 2022 recipients of the UVM Foundation’s Eugene and Joan Kalkin Lifetime Distinguished Leadership Award

82
Nancy Ellen Battey was excited to see Peggy (Bolton) Crisman, Julie Jones, Bonnie (Ouelette) Niles, and Alicia Good in Colorado to cele brate their 40th reunion. Audrey Mello Ham mer shared news of an Alpha Chi Omega recon nect this summer with Amy Aronoff Blumkin and Ilyse Wolfe Tretter. Amy London works in professional theatre in South Florida, is mom to three amazing kids, and is forever grateful for her time at Royall Tyler Theatre at UVM. Laura Vagts McInerney writes in memory of one of her dear est friends from UVM and beyond: Carl B. Rus sell. “Your friendship brought me so much laugh
Dan and Carole, we’re deeply appreciative of your many contributions which, like those of Eugene and Joan Kalkin, have been multifaceted and transformational. On behalf of a grateful University of Vermont community, thank you.
84
Jon Feidner received a 2021 Latin Grammy award for Producer of the Classical Album of the Year: Latin American Classics, Kristhyan Benitez, Piano on the Steinway & Sons label. We heard the good news that Grant McCargo is the co-founder and CEO of Urban Villages, a firm that broke ground in Denver, Colo., on Populus, which may be the first-ever car bon-positive hotel. After working as a planner for the city of Burlington, Vt., for over 26 years (the last 14 as the director of planning), David Ebbetts White retired in November 2021. In January 2022, he started a consulting business (sterlingmoun tainplanning.com) through which he advises a national clientele on land-use planning and devel opment code projects.
Send your news to –UVM Alumni Association 61 Summit Street, Burlington, VT 05401 alumni.uvm.edu/classnotes
85
Harriet Brown Dickerson was thrilled to have attended UVM’s grad uation in May—her daughter Lucy Dickerson ’22 graduated from the Grossman School of Business with a specialty in market ing. While at the graduation, Harriet’s family gath ered with her good friend and former roommate Liz Nixon’s family. Liz kindly saved the Dicker sons some prime seats on the Green! Lucy is cur rently working in Loudoun County, Virginia while planning to get her real estate license, missing her best UVM buddies, Kayla Brennan ’21 and Mor gan Gamans ’22. Luckily, the family and friends got to enjoy a wonderful vacation on the ocean in June. Patricia Anne Faass shares that she opened cannabis dispensaries in Sturbridge and Province town in Massachusetts last year. Ned ’84 and Tina Wittich Hickok were thrilled to welcome their first grandchild, Corbin David Hickok, in July 2022. Their son Sam Hickok ’14 and daughter-in-law Kelsey (Corbin) Hickok ’14 are both UVMers living in Col orado, and as of this writing Ned and Tina were so very excited to go meet him! Mark Stephen Man ning shared happy news of the alumni group who gathered in July to celebrate Chris Staffords’s 60th birthday, enjoying “dancing, much merriment, and some hooting!” Jim Lyons ’86, Steve Znam ierowski, Jeanette (Darling) McGinn, Walker Kimball, Taylor (Pedersen) Jordan ’14, Olivia Stafford ’20, Bill Tappan, Lorri Tappan ’83,
54 | UVM MAGAZINE | CLASS
— President Suresh Garimella
CLASS NOTES:
Mark Manning, Julie (Maryland) Shope, Steve Shope ’14, Ryan Jordan ’14, birthday boy Chris Stafford, and Nancy (Hoffman) Stafford were all able to take part. Many laughs were had telling the old Burlington stories, and all wished they could reconnect with all their old UVM friends.This group sends all classmates approaching this very special milestone wishes for a happy and healthy birthday. Arlene Waskiel McCoy and friends gathered for the beautiful wedding of her daughter Mackenzie and new husband Will Borland at the Florence Gris wold Museum in Old Lyme, Conn., on July 16, 2022. There was lots of fun and dancing and the evening wound down with Ben & Jerry’s. Among the friends in attendance were Susan (Royce) Empie, Claire (Cronin) Johnson ’83, Sue (Henderson) Cur tis, and Kathleen (Foy) Lancaster ’84. Barbara Steffens found time to backcountry ski and com pleted the team 20-mile “Patrol Race” in Washing ton state while working remotely developing new high school science curriculum on microplastics and ocean carbon with the Institute for Systems Biology. She helped her tween son navigate online learning by paddleboarding and sailing, and she supported husband Mark Rieder as he piloted a predictive modeling flu research study that morphed into the epicenter of Washington’s COVID testing in March 2020. She says it proved a marvelous time to recon nect with old and new UVM friends Bill Patton, Ted Lawrence, Deborah Freeman ’84, Sophie Gibbard ’95, and Kristy Friend ’08. Send your news to –UVM Alumni Association 61 Summit Street, Burlington, VT 05401
86Helen (Raboin) Condry is excited to announce that she passed her comprehensive exams for a doctor ate in nursing from Nova Southeastern University. She has begun writing a dissertation about endof-life care, inspired by the death of her husband. She also published an article about Progressive Multifocal Leukoencephalopathy in the May 2022 issue of American Nurse. She currently resides in Charleston, S.C., and teaches at Charleston South ern University. Alicia Bambara Fish and hus band Andrew are delighted that their youngest son, Paul, will be starting at UVM this year, joining his cousin Enrique de la Rosa. She says, “Paul is the seventh member of our family to go to UVM since my mother Nancy R. Ehrhardt ’55 grad uated! Go Cats!” George Payne and his wife, Matilda, have moved back to Lund, Sweden after four years in the village of Älmhult (IKEA headquar ters) where Matilda works. George has been with Oxford University Press for five years, selling educa tional resources to colleges in Sweden, Denmark, and Iceland. Their son Lennart is on the U15 Swed
ish National Basketball Team. Send your news to –UVM Alumni Association 61 Summit Street, Burlington, VT 05401 alumni.uvm.edu/classnotes
UVM Alumni Association
61 Summit Street, Burlington, VT 05401 alumni.uvm.edu/classnotes
87
Class Secretary Sarah Reynolds shares good news from the Herrera Family: Guillermo Herrera, son of Mar cia (Conroy) Herrera and Willie Herrera, mar ried Yvette Gong at the Boston Public Library on June 11, 2022. Alumni attendees included Carol (Brinckerhoff) Henderson, Keri (Wolfson) Craft, Sarah (Vaden) Reynolds, and Jenni fer (Kohnen) McNair. Doreen (DeNitto) Burl iss is “so excited for her debut novel, 'We’ll Always Have Nantucket!' The book is described as, “A sum mer vacation on Nantucket doesn’t feel quite the same as it used to for 27-year-old Teddy trying to nail down her post-grad future, or for her 53 yearold widowed mom, Sadie, trying to climb out from under the sugar-spun past and the weight of mem ories.” Kristen (Lombard) Smith and friends gathered on Cape Cod for the 35th annual celebra tion of friends from Marsh-Austin 3rd. Members of the Classes of ’87, ’86, ’88, plus spouses and chil dren (most older than the alums were when the tradition began) enjoyed their annual highlight of the year. Evan Shelby is proud to announce that his son Dylan Shelby ’22 graduated from UVM this spring. Linda Sylvester writes that she is honored to be a recipient of Liberty Mutual’s 2021 Diversity, Equity & Inclusion (DEI) Award. Help ing to create lasting value and impact, promote change, and raise awareness of DEI is an effort that she is passionate about. Send your news to –UVM Alumni Association 61 Summit Street, Burlington, VT 05401 alumni.uvm.edu/classnotes
88Karla Galfetti Smith writes, “My family is well. My two daughters are flourishing—the older graduated from Northwestern University and has returned to South Korea on a Critical Language Scholarship. This experience will be followed by a Fulbright Scholarship back in South Korea in January 2023. My younger is studying biomechanical engineer ing materials at Case Western Reserve University.” Jennifer (Jokinen) Small is celebrating the 5th anniversary of owning and operating the Golden Prairie Bakery in Laramie, Wyo., which is located in a cattle pasture on the way to the Snowy Range mountains. She invites all to look them up“ and stop by for some delectable bakery treats!” Mitch ell Jay Katz and his wife, Christine Neville, are pleased to announce their son, Ben, will be attend ing James Madison University this fall. They live in Falls Church, Va., and also have a 14-year-old high school first-year, Emma. Sandra (Spitzmiller) Ferrick and husband Tim are the proud owners of Northwave custom windsurfing sails in Hood River, Ore., and are now an official GoFoil center.
Send your news to –
89
John Chaisson runs “the Privacy Pro gram at Prime Video which is by far the most interesting job I’ve had since being the Cynic’s photo editor. Kids are great: Lach lan (14) is going into high school and loves his water polo team and surfing. Grace (12) is our lacrosse kid, who loves to ski and is going into seventh grade at Germantown Friends in Philadelphia. She’s keen on UVM pre-med so we’ll see. Wife Katherine is great and looking forward to some calm around the house as our son is heading to boarding school for 9th grade. I stay in touch with a handful of classmates on a monthly basis and just need to get up to Ver mont more to ski this winter.” Sarah Cioffi currently serves as the K-12 director of English as a new lan guage and world languages in the Shenendehowa Central School District in her hometown of Clif ton Park, N.Y. She also teaches in the graduate pro grams at both Bard College and Clarkson University and is currently working on her doctorate in educa tional leadership at Russell Sage College. Sarah reg ularly visits with Glenn Griesser ’88 and Court ney (Smith) Griesser at their home in Shelburne, Vermont. Now that her oldest daughter is living and going to school in Paris, and her youngest is headed to college in a few weeks, Sarah hopes to get Court ney, Amy Raab Macaluso, and Ellen Stecklow Marcus back together for another Fall Girls’ Week end! In April 2021, Donald Anthony Fox said he was excited to visit Burlington once again as their daughter, Caroline Fox, is now a Catamount in the Class of 2025. They’re looking forward to three more years of visits to campus, which has changed a lot since the 1980s! Maureen Donahue Hardwick was named office leader of Faegre Drinker’s Wash ington, D.C., office, where she had previously served as co-leader. She provides strategic, legal, and busi ness advice to global pharmaceutical, biotechnol ogy, and medical device companies to advance regulatory, policy, scientific, and research objec tives. Edward Kent Herdiech and his wife Kim began their “next chapter by purchasing Autumn Hills Orchard in beautiful Groton, Massachusetts.” They are now entering their second season and invite UVMers to visit them for pick-your-own ber ries, peaches, grapes, apples, and pears—and find them for a VIP tour of their stunning 90-acre prop erty. Meg (Terry) McGovern says she was lucky enough to be on a ferry to Nantucket and witness Adam Nagler arriving after his 600-mile paddle board trip to raise money for a mental health clinic on Nantucket. She says, “He is incredible!” Seth Moeller is living in Lexington, Mass., and is mar ried with three daughters. He runs KGA, Inc., a firm providing employee assistance services to New England employers. He writes, “Hi all. Ski on!” Send your news to –UVM Alumni Association
61 Summit Street, Burlington, VT 05401 alumni.uvm.edu/classnotes
FALL 2022 | 55
alumni.uvm.edu/classnotes
MAIL YOUR CLASS NOTES: UVM Alumni Association 61 Summit Street, Burlington, VT 05401 SUBMIT YOUR
alumni.uvm.edu/notes
90
Dan Beaupré and family are happy to have returned to Middlebury, Vt., after eight years in Washington, D.C. Dan completed 20 years at National Geographic and now has a consulting practice called One Giant Leap as well as a new business, GraspXR, produc ing virtual reality for educational use. Best of all, he says, “Our son Nick will be a freshman at UVM start ing in fall ’22!” Aviva Friedman Black has started her own business, Family Love Letters, to capture individuals’ stories to be shared with family. She says it’s the best job. Eliza Fisher Cain writes, “My daughter is entering the Honors College and CESS in a month! I am excited for her to dive into all that UVM has to offer. She will certainly be focused and engaged in her learning!! I look forward to recon necting as a parent.” Bob Huseby ran into Rich First at the Phish show in Bangor, Maine! Sean Martin shared news of a Catamount reunion trip to Alaska’s Denali National Park. Members from the Class of 1985-1990 included Peter Allen ’85, Terry Amodio ’86, John Arena ’88, Paul Arnaud ’86, Chris Arrau ’83, Jonathan Bates ’00, Scott Bonneville ’84, Howard Brophy ’87, David Caminear ’86, Bradford Chervin ’86, Cary Clark ’83, Brendan Curran ’84, Jim Donahue ’85, Billy Gage ’87, David Galfetti ’87, Glenn Griesser ’88, Bob Handal ’89, Pete Harper ’88, Edward Howe ’87, Neil MacNeill ’85, Ken Mazer ’85, Peter Monte ’87, John Morse ’85, Mike Nedrow ’86, Steve Pazienza ’84, John Spencer ’86, Steven Vincent ’88, and Adam York ’85
Send your news to –UVM Alumni Association
61 Summit Street, Burlington, VT 05401 alumni.uvm.edu/classnotes
91Carl Brody, Rebecca (Krieger) Brody ’92, and Jill Brody ’24 are excited that Robin Brody chose UVM! Robin became a Catamount this fall. “Bro Cats Bro!”
Send your news to –UVM Alumni Association
61 Summit Street, Burlington, VT 05401 alumni.uvm.edu/classnotes
92Jonas Kron has been named to the “Fast Company Most Creative Peo ple in Business 2022” list, in recogni tion of his impact as the chief advocacy officer at Boston-based Trillium Asset Management. Sheila Mehta-Green was elected to her school commit tee earlier this year in Bedford, Mass., She currently is a director in the Education Division at Apple and an adjunct faculty member in the Sociology Depart ment at Middlesex Community College and North eastern University. When she wrote she was looking forward to attending her 30th UVM reunion with family and friends this fall.
Send your news to –UVM Alumni Association
61 Summit Street, Burlington, VT 05401 alumni.uvm.edu/classnotes
93
Sanford “Sandy” Scott Bernhardt writes that he had an “amazing” spring of 2022 reconnecting with a big group of classmates and teammates following the UVM men’s lacrosse team’s historic season. He was able to connect with MJ Berman ’93, Scott Bevill ’95, Adam Cate ’93, Dean Corkum ’87, Tom Egan ’93, Drew Flood ’91, Anton Iamele ’94, Chris McCabe ’91, Doug Moses ’03, Ian Paisley ’93, Kamati Pinkston ’95, Tom Rietano ’90, Joe Scharfenberger ’94,Todd Warden ’90, Paul Weiss ’90, and many others. He says that the Ver mont men's lacrosse catamount club did a great job organizing gatherings and engaging alums. Next year they are hoping for an even larger turn out! Elizabeth Murphy Clark has written her first children’s novel inspired by J. R. R. Tolkien, work ing with a lovely group of editors in England. She thanks all her UVM professors and “the Inklings!” Daniel Morse Goldthwait saw Tom Egan, Jody Scharfenberger ’94, and Tim Shannenhan ’91 at a lacrosse tournament in Maryland at the end of June. He also caught up with Brandt Rider ’92 and Crawford Hubbard ’92 and says it was excellent to see them all. Joanne Elizabeth Stewart Kloker is now a faculty member teaching environmental sci ence and biological diversity at Fort Peck Commu nity College on the Fort Peck Indian Reservation in Montana.
Send your news to –UVM Alumni Association 61 Summit Street, Burlington, VT 05401 alumni.uvm.edu/classnotes
96Shauna (Antoniuc) Anderson and her husband Brandy Anderson G’04 started Andersonia Winery in the Sierra Foothills of California. They make natural wine and their tasting room was scheduled to open in Septem ber. Their six kids will be helping with the business.
Send your news to –Jill Cohen Gent jcgent@roadrunner.com
97
Dana Horowitz has become a senior development executive at UJA Federa tion New York – Westchester, working with the Business and Professionals Division. Deir dre (GaNun) Lester was recently appointed CEO of Outsider, a media and lifestyle brand which celebrates American culture; she was most recently CRO at Bar stool Sports. She resides in Rye, N.Y., with her husband and two sons. Christina (Brownell) McCaffrey is planning to retire this fall after 25 years at UVM Medi cal Center as a neurosurgical operating room RN. She says she’s hoping to spend more time with her fam ily including a new great-granddaughter. Judy Nagai joined the University of Hawaii Foundation as senior executive director of campaign planning.
Send your news to –Elizabeth Carstensen Genung leegenung@me.com
98
Send your news to –Ben Stockman bestockman@gmail.com
94
Jennifer Lynn Brody says hello to all her classmates! “My husband Jason and I are so pleased to be supporting our 14-year-old daughter, Joslan, as she enters high school this fall. I still think of many UVM memories as I share ‘do as I say, not as I did’ lessons with her. I am still going strong as a psychologist training future psychologists at a non-profit mental health services agency in upstate New York. The future looks bright!” Liz Clark Fariello writes she “had an amazing trip to Key West with Roxane (Rohowsky) Mulenex, Maria Bremis, Lisa (Ferland) Schmitt, and Melissa (Kissell) Kumar to celebrate a big birth day year. Regrettably, we neglected to re-enact the 'Duran Duran Rio' video while on the boat! Next time!” Kurt Mayr has joined bankruptcy and trial law firm Glenn Agre Bergman & Fuentes, LLP as a partner in their New York office. He was most recently head of the bankruptcy practice at Morgan Lewis & Bockius, LLP.
Send your news to –UVM Alumni Association 61 Summit Street, Burlington, VT 05401 alumni.uvm.edu/classnotes
95Kevin O’Leary and his wife, Kristina, celebrated their 20th anniversary on August 3, 2022 with their three chil dren, Ryan (18), Kiera (15), and Kylie (12).
Send your news to –Valeri Susan Pappas vpappas@davisandceriani.com
99
Amber (Fisher) Rich, G’15 has opened an anesthesia practice, Anes thesia Associates of Vermont, with her partner, Dr. Vincent Miller. Starting in Septem ber 2022, the practice is providing anesthesia ser vices for the Green Mountain Surgical Center in Col chester, Vt.
Send your news to –Sarah Pitlak Tiber spitlak@hotmail.com
00
Desereè Hubbard and her hus band, David, are proud to announce that their daughter, Ainsley Hub bard, will be attending UVM in the fall. Ainsley will be majoring in public communications and will be a member of the varsity field hockey team. Go Catamounts! After a lifetime in Massachusetts and Vermont, Heidi Berkowitz Sadler and her fam ily have, “peaced out and moved to Park City, Utah! I'll be teaching in the English Department at Utah Valley University and hopefully skiing 100 days with my husband and two boys.”
Send your news to –
UVM Alumni Association
61 Summit Street, Burlington, VT 05401 alumni.uvm.edu/classnotes
01
Send your news to –UVM Alumni Association 61 Summit Street, Burlington, VT 05401 alumni.uvm.edu/classnotes
56 | UVM MAGAZINE
BACK ON CAMPUS
Meg Lipke ’91
For painter Meg Lipke ’91, UVM was both her childhood home and the birthplace of her earliest creative instincts. “My brother (Dan Lipke ’95) and I were the quintessen tial faculty brats,” says Lipke, whose father taught art history at UVM and mother taught art history and studio art across the street at Trinity College. Now a fulltime artist in the Hudson Valley, Lipke is still evolving in her approach to painting. Her large-form abstract pieces defy con ventional notions of the medium. Rather than starting with a stretched, flat canvas, Lipke crafts her own multi-dimensional canvas supports that lend a sculptural ele ment to her work.
“We usually think about a painting as being flat, but I really wanted to rein vigorate painting and bring some of the confrontation that first-wave feminists brought to their work, in which they were engaging new forms, trying to break out of older, fixed disciplines like paint ing or sculpture and creating new hybrid forms that didn’t have a history of being male-dominated.”
In the spring of 2021, with support from the Mollie Ruprecht Fund for Visual Arts, Associate Professor Steve Budington invited Lipke to return to UVM virtually to share wisdom and advice with two art and painting classes. She encouraged stu dents to experiment fearlessly and find their own voice in their work.
“The visual arts can all be used to express, ‘I was here, and this is how I felt joy’ or ‘This is how I felt about life.’ And I think that’s just so basic and human. It’s how we communicate with each other in a visual or sensory language that doesn’t require words. There are so many differ ent ways of understanding each other, other cultures, other times and histories and voices. It makes us richer and more empathic as a society to engage and prac tice the arts.”

WILLY SOMMA
A Pop of Color
Arealles Ortiz ’15
Arealles Ortiz ’15, owner and operator of Curly Girl Pops, runs one of the coolest culinary ven tures on the Vermont food scene. Her whole some, small-batch popsicles have become a summertime staple at farmer’s markets and small shops across the state. With frozen treats featuring vegan, health-forward ingredients like hibiscus tea, blue spirulina, goji berries, and spinach—sweetened with Vermont maple syrup, naturally—the business student turned nutrition and food sciences major has found her niche by following her passion.
“I feel like it's always been inside of me,” says Ortiz. “I've always wanted to pursue something different and be my own boss, I guess. And I've always been interested in food since I was really little, playing with Easy Bake ovens and cooking with my grandma when she would come visit from Puerto Rico. Just having memories around food, that's really important to me.”
Ortiz says her business and colorful creations are rooted in her food science background and Puerto Rican heritage.
“The inspiration behind it was a love for food and nutrition, stimulating people's senses through color and getting them interested in the rainbow of fruits and vegetables. And then Puerto Rican culture, which is eating tropical fruits of all vibrant colors.”
Another color that’s important to Ortiz? Green. Sourcing organic, local ingredients and using sustainable, biodegradable packaging is at the core of her business model. And so is serving up smiles. She puts in a lot of hours as a “solopreneur,” from working with local farm ers to producing and packing pops, to operating her mobile popsicle stand in the shade of a rain bow-colored umbrella. But on the other side of all of that effort, she says, there is a payout.
“What I love most is people's reactions when they have a Curly Girl popsicle for the first time and really like it. The joy makes everything worth it for me.”

ISORA LITHGOW ’16, G’20
CATAMOUNT NATION
02
03Class Secretary Korinne Moore
Berenson shares that Heather (Pearson) Roell has had a busy 2022. In February, she married Josh Roell. She also shares that she will be starting her dream job in August as the district literacy specialist in Seminole County, Fla., Bryan Carnahan checked in with stories from adventures and connections around the world. In late May, he travelled to Bavaria, Ger many to see the Oberammergau Passionspiele, which has been presented every 10 years for more than 400 years; this edition had originally been scheduled for 2020. He visited several Bavarian cit ies and towns as well as the countryside and even visited family that he had not seen in 20 years. As if that was not enough, he flew directly from there to Brazil to attend a friend’s wedding, and then after returning to New Hampshire, another friend’s wed ding just a week later. In July and August, Bryan has been giving “trail magic” to Appalachian Trail trek kers in the White Mountains of New Hampshire, just 1.5 hours from his house. This involved grill ing some bratwurst and veggie burgers as well as providing fresh fruit and some local craft beers and artisan soda and, most importantly, water. In November, Bryan will run the New York City Mar athon. Ash Desmond relocated from Portland, Ore., to the Boston metro area with his wife, Chris tina, and their two young daughters. He is glad to be back in New England and closer to family and friends in Vermont. He recently accepted a job with the Massachusetts Department of Environmental Quality working on hazardous sites management.
Send your news to –
Korinne Moore Berenson
Korrinne.d.moore@gmail.com
Kristen Dobbs Schulman
kristin.schulman@gmail.com
06
Jane Trivett writes with the happy news that, “On July 23, we celebrated the marriage of Garrett Sabourin to Allie Platt in Bend, Oregon. Sarah Poirier (hus band Chris), Lisa Hovey (husband Scott), Caitlin and Steve DiMillo, Jennifer Fifield (husband Ricky), Mark Weldon (wife Tracy), Alex Borg ’05, Carl Hanson, and Dave McAndrew (wife Juliet) all made the wedding even more fun!”
Send your news to –Katherine Murphy kateandbri@gmail.com
ward to assisting new staff as they learn about this treatment. Kimberly (Shane) Hochradel was promoted to vice president, chief privacy officer of Premier, Inc., a health care improvement company. While Ellen Rae Stanley continues to teach in an after-school program, she has also started Pais ley Scoops Gelato and Sorbet, using local Franklin County, Vt., ingredients and milk from her family’s farm. Find them at a farmers’ market north of Burl ington (they are involved with several!).
Send your news to –David Volain david.volain@gmail.com
07
Nate Methot has published "Life Derailed: My Journey with ALS," a memoir beginning with his first mys terious symptoms in 2010, to his ALS diagnosis in 2011, until (almost) present day. It was published by Onion River Press in June 2022; buying options and more information are available at natemethot.com.
Send your news to –Elizabeth Bitterman bittermane@jgua.com
08
Christopher Edward Towne was selected for the Bi-State Primary Care Association’s Hunt Blair Leadership Award (Vermont) in April 2022. He was nominated by his peers and selected for his “extraordinary leadership responding to today’s challenges while creating better access to care tomorrow.”
04
Send your news to –Kelly Kisiday kelly.kisiday@gmail.com
Abby Goode completed her first book, "Agrotopias: An American Liter ary History of Sustainability," which as of this writing is set to be released in fall of 2022 from the University of North Carolina Press. Goode is an assistant professor of English at Plymouth State Uni versity in New Hampshire. She teaches and publishes in the fields of American literature and the environ mental humanities. Not only did she publish a book, but she and Evan Press ’90 are excited to announce that they got married on June 25, 2022. Aaron Rich Tolbert accepted the position of assistant vice pres ident of academic affairs at Hartwick College in One onta, N.Y. DaVaughn Vincent-Bryan has been named the inaugural director of involvement and student unions in the Division of Student Affairs at the University of Pittsburgh. He is also currently pur suing a doctorate in education in Pitt’s School of Edu cation with a research focus on fostering cohesion through shared mission development. His personal mission is to “make big places feel small.” Send your news to –Elizabeth Bearese ebearese@gmail.com or Emma Grady gradyemma@gmail.com
05
Melissa Tayla Quine and her hus band welcomed future Catamount Logan Francis in March 2021. They live in San Francisco. Catie Shuman married Keith Damanti on March 5, 2022 in Columbus, Ohio. These huge ice hockey fans simultaneously celebrated their love for each other and their love of hockey by exchanging vows at Nationwide Arena in front of the Blue Jackets’ well-known 1857 Napoleon replica cannon. After exchanging vows, they cheered on the Blue Jackets as they played the Boston Bruins.
Send your news to –
09
Rachel Bensen ’11 and Dan Bensen celebrated the birth of their daughter Eliza in October 2021! Zoë Orr Gandee and her family are pleased to announce the arrival of their daughter, Matilda Orr Gandee-Riggs, and report, “She’s already making a name for herself, protesting at the Supreme Court with her mom in defense of bodily autonomy and choice.” Nydia E. Guity was promoted to lead psy chotherapist at Field Trip Health in Atlanta, Ga. She enjoys supporting clients that are exploring Ket amine assisted psychotherapy (KAP) and looks for
10
Kate Ash celebrated her marriage to John Vrolyk on July 8, 2022 in Man chester, Vt. Alumni in attendance included Chelsea (Brasel) Mares, Sara Fox, Jenna (Isaac) Wilson, Rachel Thurrot, Ben Mervis ’12, Bryce Jones ’11, Julia Michel ’11, Kyle Coulam ’11, Frieda Arenos ’08, Emily Anne (Strattner) Sampson, Mike Leelman, and Kieran Fane-Hervey. Kate and John live in Washington, D.C., where they both work in pub lic policy. Kate serves as the consulting director of the National Governors Association Workforce Innovation Network and remains involved in UVM as an advisor on the University Engagement Advi sory Council and a UVM Foundation Fellow. Phil lip Harrington shared news of five UVM civil engineering alumni who worked on the $73-mil lion North Hero/Grand Isle drawbridge project in northwestern Vermont. Phil is the resident engi neer and worked with other CEMS alumni who consulted on the project, including inspector Jacob Sprague ’14, inspector Nick Brustin ’14, inspector Eric Corredera ’14, and chief inspector Cam Michaud ’14
your news to –Daron Raleigh raleighdaron@gmail.com
11
Casey Leigh Cullen-Woods joined Barclays in May as global lead for sus tainable design and operations, respon sible for leading the bank in their commitment to net-zero carbon by 2035. Dustin Evatt-Young, a 2011 graduate of UVM’s Higher Education and Stu dent Affairs (HESA) Program, has accepted a new position as assistant professor of higher education at Western Carolina University in Cullowhee, N.C. Bob Just is excited to share that he was recently promoted at the University of San Francisco where he is now serving as the program director for the Change the World From Here Institute. The Insti tute focuses on developing leadership programs for undergraduate and graduate students who are interested and passionate about social change. Shannon Kostin, M.D. wed Robert Beringer on April 30, 2022 in Avon, Conn., with many UVM friends in attendance and a few celebrating from afar with new babies at home including Alyssa (Frediani) Rella ’22 and Jenna (Banning) O’Donnell ’15. In the bridal party were the bride’s sister, Susan (Kostin) Washburn, M.D. ’16, and Elizabeth Arthur ’12. Nehemie Moise wrote
FALL 2022 | 59
Send your news to –UVM Alumni Association 61 Summit Street, Burlington, VT 05401 alumni.uvm.edu/classnotes
Send
| CLASS NOTES
MAIL YOUR CLASS NOTES:
UVM Alumni Association
61 Summit Street, Burlington, VT 05401
SUBMIT YOUR CLASS NOTES: alumni.uvm.edu/notes
over the summer to let us know that she and Anthony Young were looking forward to their wed ding in September 2022.
Send your news to –Troy McNamara troy.mcnamara4@gmail.com
12Daniel Levi Abrams graduated in May with a Ph.D. in physics from the University of Virginia. Aimee (Beach) Baumgartner, co-owner of Cloud Mountain Kombucha brew ery located in Champaign-Urbana, Ill., welcomed her first child, daughter Emerson, in April with her husband and business partner Andrew Baumgart ner. Alex Fogel writes, “I’ll be returning to New York City this summer to join the NYC Teaching Fellows program. I’ll be teaching Spanish at a Department of Education high school in Brooklyn while working on a master’s at City College. Let me know if you’re in the area!” Ray Edward Leslie completed his res idency in psychiatry at Temple University Hospital and would like to thank the professors who shaped his time at UVM, especially Bryan Ballif, Ray Vega, and Alex Stewart.
Send your news to –Patrick Dowd patrickdowd2012@gmail.com
13Jenny Klein married Patrick Bousquet on August 13 in Quechee, Vt. Katie Kimball and Catherine Bekel were bridesmaids, and alumni Martine Wong, Thomas Cohen ’12, Carolyn (Herkenham) Cusick, and Jon Cusick ’12 also attended. Jenny is so grateful to have found such wonderful life long friends at UVM and that they were able to cel ebrate with her and Patrick. Send your news to –UVM Alumni Association 61 Summit Street, Burlington, VT 05401 alumni.uvm.edu/classnotes
14Class Secretary Grace LB Eaton writes to share the news of several classmates “Julia (Anderson) Crane G’18 and Chris Crane welcomed baby Aiden into the world in June 2022. Sam Kahn-Arcangeli married William Ung on 02/02/2022 at 2:00 p.m. in Boston. On a beautiful day in May, Devon Mead owcroft married Brian Mills in Colorado Springs, Colorado. Her UVM family was there to help cel ebrate, too! Taylor Pedersen Jordan ’15 and Ryan Jordan welcomed their first child, Cooper Pedersen Jordan in March 2022. And on March 1, 2022 (Vermont Town Meeting Day), Thomas Renner was elected to the Winooski City Council.” Tara Bradley and Nicholas Stein married on May 17, 2022. Allie Goldberg is “excited to be serving as the New York City chair for the Next Generation Alumni Committee for the 3rd year in a row. I love meeting new alumni and getting together with my UVM crew. This past weekend, I attended the wed ding of my friend Evan who was also in the College of Education and Social Services, and there was a huge UVM turnout!” Melissa Guerrero Geli
nas and family are excited to welcome baby John Martin to the family, born in February! Kathleen Murray and Aron Griffiths of Williston, Vt., married in Kauai, Hawaii, on July 15. Kylie McNamara, Sarah Leidinger, and Rebecca Hayes were in attendance. Hillary (Laggis) Ribaudo and Teddy Ribaudo welcomed their son, Theo, in November 2021. Aaron Szotka began a career as a natural resource specialist with the Army Corps of Engi neers, Fort Worth District, and says Bonnie Kelley ’17 will continue her career with the U.S. Fish and Wildlife Service’s Office of Law Enforcement, trans ferring from Nogales, Ariz., to Fort Worth. Send your news to –Grace Buckles Eaton glbuckles@gmail.com
15
Chris Damiani and Michelle Gold smith were married at the Intervale in Burlington on June 25, 2022. Chris and Michelle met on a sunset hike up Camels Hump and began dating during their time as UVM Out ing Club leaders. We hear that Anthony Martel is diligently working in South Africa advocating for the Nelson Mandela Bay Water Crisis Committee. Katie Staley G’21 and Samuel Ingraham were married on July 23, 2022 at the Intervale in Burling ton among a group of friends and family. They then proceeded to “shake it all night long” on the dance floor and are having a wonderful time ever since— and hope that other UVM alums had a similarly great summer! Emily Wiggans was honored to be a bridesmaid in the wedding of Emily (Edgar) Swanzy on April 30, 2022. They met as roommates freshman year in University Heights South, back in fall of 2011, with “three Emilys in a four-person suite!” “Wiggans” wishes “Edgar” and her husband, David, the lifetime of happiness they deserve!
Send your news to –UVM Alumni Association
61 Summit Street, Burlington, VT 05401 alumni.uvm.edu/classnotes
16Eric Denardo ’13 and Meagan Beley-Finnemore G’16 got married at the Mountain Top Inn in Chittenden, Vt., on December 17, 2021. Shannon Hogan earned a Master’s of Science in marine science and tech nology from the University of Massachusetts Bos ton earlier this year and is now a researcher at Urban Harbors Institute in Boston. Charles Dyson White ’15 writes with the happy news that his sister Anna White and Stephen Richards were married on August 13, 2022. They met while living in McAuley Hall their first year at UVM.
Send your news to –UVM Alumni Association
61 Summit Street, Burlington, VT 05401 alumni.uvm.edu/classnotes
17Nora Awadallah is “very proud and excited to say that I have successfully defended my Ph.D. in Neuroscience! This would not be possible without all of my amazing professors at UVM preparing me for this journey!”
Saritha Beauchamp has graduated from medi cal school with her M.D. and M.P.H. She has moved to Philadelphia for her pediatrics residency. Gina Castellano has spent the last five years at the New Jersey Cancer Institute doing research in lung can cer treatment and just earned her Ph.D. in cellu lar and molecular pharmacology from Rutgers Uni versity. She is looking forward to the next chapter of her career as she finds a job in the pharmaceuti cal industry to continue cancer research. Tim Cece has recently left his role with The Essex Experience and will begin a new role as project manager for Class Four. He says to get in touch if he can help with your marketing plans, and he is excited about stay ing in Burlington and remaining involved with UVM. Rebekah Cheresnick is excited to announce that a book she illustrated has been published. Writ ten by Montserrat Coughlin Kim and illustrated by Rebekah in watercolor and ink, "My Dad and the Dragon" shows what life is like when a father is diagnosed with cancer. You can visit whenad ragoncomes.org to find more information, helpful resources, and to purchase or donate the book—all profits are donated to organizations that help chil dren in these circumstances. Rebekah is currently living in central Vermont with her boyfriend and dog, illustrating the second book in the series. Mar ion R. Cundari joined the UVM NextGen Council this summer. She’s also back in Burlington working remotely for REsurety, where she leads the trans action analytics team. Outside of work she’s adven turing through Vermont with her one-year-old dog, Bruno! Samantha (Ryea) Duchesneau and Alex Duchesneau G’14 welcomed their daughter, Rea gan Belle, in early November 2021 in Charlotte, N.C. Reagan loved watching the Catamounts on televi sion during her first March Madness, and she looks forward to being part of the Class of 2042. Jake Guarino writes that he “wanted to provide a profes sional update on my career and let all alumni know I am available to serve as a mentor or would love to connect in a networking session. I recently started as a corporate development associate at Spotify based in NYC. Would love to connect with anyone in the music or traditional finance space. As part of my role we are tasked with evaluating high-level stra tegic goals for Spotify as well as live deal execution. Happy to discuss in more detail in person in NYC or via Zoom!” Dan Kopin and Gracie Harvey ’18 had a blast at the Catamount Summer Social in June 2022. They hope to see area alumni at an in-person event soon! Ian Joseph McHale started a new position as the director of overdose education and Naloxone distribution for the New York City Depart ment of Health and Mental Hygiene. Simone Sun Washington graduated with a J.D. from Washing ton and Lee University School of Law on May 13, 2022.
Send your news to –
UVM Alumni Association
61 Summit Street, Burlington, VT 05401 alumni.uvm.edu/classnotes
60 | UVM MAGAZINE | CLASS NOTES
18Wes Brown writes to say that Chris Cooney ’19, Andrew Farrell ’18, Ferris Garel ’19, Mark Gildea ’19, Mitch Maver ’20, Hugo Rapp ’19, and he spent Memorial Day on Cape Cod, which is “no North Beach,” but they had a great time.
Send your news to –UVM Alumni Association 61 Summit Street, Burlington, VT 05401 alumni.uvm.edu/classnotes
19Hayley Barriere is still living in the Burlington area and is staying con nected to the UVM community by vol unteering through the NextGen Alumni Coun cil. She was very excited to travel to Minnesota this spring to meet her new 3-month old nephew, Summit. Sophie Behrend was looking forward to heading back to New England this summer with her dad and fellow UVM alum Daniel Behrend ’66. She said, “We’ll be spending time together in Maine but hope to return to Vermont together soon! Cheers to a healthy and happy summer ahead!” Cheryl L. Herrick G’19 says, “As of April 2022, I’ve joined the awesome folks on the Com munications & Stewardship Team at the UVM Foun dation—which means I get to work on Class Notes and read everyone’s news. Keep ’em coming!” Hai ley Nelson graduated from Columbia Univer sity with a master’s in social work in May 2022. Andrew Barrett Simeon offers congratulations to the UVM men’s lacrosse team on winning backto-back America East Championships! “Let keep this train rolling! #RollCats” Sarah Lyman Ticho nuk G’19 is running PurplCouch, an online busi ness supporting folks on the divorce journey. She says her proudest moment was when a reporter from Burlington’s alternative weekly Seven Days called her a “Nick Fury of Divorce!” Neil Wood is beginning a Ph.D. program in biophysics at Johns Hopkins University. After living in the U.S. for seven years, Yi-Chuan Yu is starting a Ph.D. program in epidemiology at McGill University in the fall of 2022. He is excited to return to this beautiful part of North America.
Send your news to –UVM Alumni Association 61 Summit Street, Burlington, VT 05401 alumni.uvm.edu/classnotes
20Anneke Leigh Butkus that she, Julie Belanger Caminear, and Anna Sullivan are living together happily in Cambridge, Mass., with their two cats, Banjo and Tucci. A. Evans writes, “It’s been almost a year since I moved to Paris, France after being offered a job as Enrollment Advisor for Hult International Busi ness School. Thanks to the UVM Career Center who helped me learn to network and write cover letters, I was able to get my dream job in my dream loca tion. Some of my fellow UVM friends have already come to visit and I love taking them around the city and sharing my success with the people who care about me. Dreams do come true!” berg is a project manager with WebMD and has
volunteered to serve on the UVM Alumni Asso ciation Board of Directors. As a student, Max sat on the board as a representative for the Student Alumni Association and is excited to continue his involvement with UVM! Kailey R. Loughran started working as an archaeologist with the U.S. Army Corps of Engineers at their New York district office and would like to reconnect with former classmates who are also located in the NYC area. Danielle Marie Morris shares that she has “suc cessfully survived the first two years of working as a nurse during a pandemic! First year in the hospi tal and the past year as a school nurse. Happy to now enjoy the summers off!” PJ Solomon writes that he’s moving out to Salt Lake City. Send your news to –UVM Alumni Association 61 Summit Street, Burlington, VT 05401 alumni.uvm.edu/classnotes
Elizabeth Moran has finally self-published her first children’s book, "The Adventure of Cordelia and Dibbles", which she describes as “an engaging, mythological, hero and quest story for children ages 7-10.” The book was written to explore the components of literacy on the way to her future career as a speech and language pathologist. Emily thanks the UVM Office of Fellowships, Opportu nities, and Undergraduate Research for financial support, and Shelly Velleman (CNHS), Jane Petrillo (CDAE), and Steve Kostell (CDAE) for mentorship. See her website literasee.me for more information. Send your news to –UVM Alumni Association
61 Summit Street, Burlington, VT 05401 alumni.uvm.edu/classnotes
22

Send your news to –UVM Alumni Association

21
Three months after graduating, Sophia Boschetto moved to New York City and began working in the film indus try. In October 2021, she landed her first job as the sound utility technician on the Netflix origi nal film “Christmas with You,” which will premiere in November 2022. She says to keep an eye out for this holiday rom com! Sophia Mellen says she wasted no time to start her next degree and dove right in to a master’s program in exercise science at Merrimack College, which she received in May of 2022. She now is a geriatric fitness specialist at a Massachusetts retirement community and looks forward to starting a part-time position as a health coaching mentor for UVM. She is excited to stay part of the UVM community, even from afar. Emily
61 Summit Street, Burlington, VT 05401 alumni.uvm.edu/classnotes
| 61
WHAT'SONYOUR MIND? Alumni Discount
UVM
The UVM community is an extraordinary body of students, faculty, staff, graduates, volunteers, and friends. Every member of our community is valued, and we are saddened by each loss. See the full alumni in memoriam list at alumni.uvm.edu/memoriam.
62 | UVM MAGAZINE | CLASS NOTES
Dorothy Franklin Cole ’43 died July 6, 2021. She graduated from UVM with a degree in elementary education and a minor in psychology. Dorothy was a member of Sigma Gamma, and in the early months of World War II volunteered to be an airplane spotter, watching for enemy aircraft from the top of UVM’s Old Mill tower. In September 1943, she began teaching in Shelburne, Vt., schools. Her family recalls that Dorothy felt that every stu dent has an education “switch,” and it was up to her to activate it. She retired in 1984 and became an energetic volunteer with UVM, supporting class reunions and connections with fellow alumni for many years.
Roberta “Robbie” Pfeufer Kahn passed away August 3, 2022. Born and raised in New York City, Professor Kahn earned undergraduate and graduate degrees from Brandeis University and, early in her career, was a member of the collective that produced the groundbreaking and influential book on wom en’s health Our Bodies Ourselves. Professor Kahn taught in the Department of Sociology at UVM from 1990 to 2009, guiding students through women’s studies courses such as Feminist Perspectives on the Western Canon, The Sociology of Health and Medicine, and The Sociology of Reproduction, among many oth ers. She is remembered as a beloved colleague, valued mentor, devoted animal and nature lover, and good friend.
Robert K. Mitchell ’68 passed away on December 13, 2021. Bob was among the most honored Catamount running backs of all time, and some say he was the best. His football prowess merit ed a scholarship to UVM where he was admired by his team mates and where he won national acclaim. He was inducted into the University of Vermont Athletic Hall Fame and the Vermont Sports Hall of Fame and recognized as one of the 20th century’s top 50 athletes from Vermont by Sports Illustrated magazine. He met his much-loved wife, Jane Fisk Kimball ’68, while at UVM. They shared a passion for education and both enjoyed long careers devoted to that field. Bob was beloved by both students and parents at Williston (Vermont) Central School in the three decades he taught there.
Rev. Roddy O’Neill-Cleary passed away on June 27, 2021. Rod dy earned a doctorate in ministry from Saint Mary’s Seminary and University and became the interfaith campus minister at UVM. In 1995, she received the Kroepsch-Maurice Excellence in Teaching Award for her course Women’s Spirituality: A Challenge to Institutional Religion. In 1997, she retired from UVM and became the affiliate minister at the First Unitarian Universalist Society of Burlington, a post that she held until 2008. She was influential as a clergy member in the passage of Vermont’s civil union law in 2000, honored with awards for her lifetime of service and activism by multiple organizations, and in her last years worked as a hospice volunteer and mentor for women in local prisons.
Lucien Paquette ’40 passed away on November 23, 2021. Born in Craftsbury, Vt., in 1916, Lucien grew up working on the family dairy farm. He graduated magna cum laude from UVM in 1940 and began a long career with UVM Extension as a county agent in Grand Isle County and then Addison County. Lucien described his career in Extension as “helping people to help themselves.” His contemporaries remember him as someone who worked tirelessly to help people make informed decisions that could improve their lives, their businesses, and their communities. He was instrumental in starting the Addison County Farm and Home Field Days in 1948, an annual August gathering focused on education, youth, family, and agricultural community. He was also the first superintendent of the UVM Morgan Horse Farm. Lucien was inducted into the Vermont Agricultural Hall of Fame in 2014.
R. Allan Paul ’53 passed away peacefully at home January 3, 2022. He lived a life described as full of love, law, and golf. Allan was a founder of the Burlington law firm Paul, Frank & Collins and served as its founding president for 26 years. A life of community leadership and service included years on the UVM Board of Trustees and two years as chair of the Board. In 1991, he was celebrated as the UVM Alumni Association Distinguished Service Award winner, and in 2006 as the Vermont Chamber of Commerce Citizen of the Year. He is survived by his wife of 67 years, Elsie Epstein Paul ’54
Marshall Webb ’72 passed away on August 11, 2022 following a heart attack while swimming in Lake Champlain. Born in 1948 on what would later become Earth Day (April 22), he and his family established Shelburne Farms the same year he graduated from UVM’s College of Arts and Sciences. In the 50 years since, Shel burne Farms has become not only a key UVM research partner, but also an internationally renowned nonprofit education center for sustainability in (and beyond) agriculture. Marshall helped create a hub for programs that interweave farming and education for all ages, and a demonstration site for work that addresses many complex ecological and social challenges. He is survived by his wife, Hon. Kathryn “Kate” (Spaulding) Webb ’75, G’80
Junru Wu passed away August 25, 2022 due to complications from Lewy body dementia. A world-renowned experimental physicist with expertise in ultrasonics, biophysics, and nonlinear physics, Professor Wu was a professor at UVM for 32 years and served as the chair of the Department of Physics for over a de cade. He received the UVM Inventors Hall of Fame Award in 2015 and was named a University Scholar in 2018 in recognition of his sustained excellence in research and scholarly activities. He is remembered for his mentorship, productive research, collabo rative spirit, entrepreneurship, and considerable university and professional service.
FALL 2022 | 63
| UVM COMMUNITY
Music Prof Set to Tour Every Town in Vermont
By Tucker Houston '22
Professor David Feurzeig wants to play a concert in each of Vermont’s 251 towns.
That’s an ambitious goal, but Feurzeig, who teaches in the Department of Music, is confident he can get it done. He launched the tour May 6 with a concert in UVM’s renovated recital hall, and he’s set a goal of completing it in five years — by the end of 2026 — playing roughly one concert every week.
The concerts are free and take place in venues ranging from opera houses to forest trails. Feurzeig plays the piano, and although he will be the featured player in each concert, he hopes to include local composers and musicians in the performances.

“One (goal) is just the idea of supporting com munity events and supporting live local perfor mance, contributing to that,” Feurzeig said. “And again, fulfilling and amplifying UVM’s mission to be a resource for the whole state.”
As for the repertoire of the 251 shows, Feurzeig said he wants to include some Vermont-themed music, music about the state, or from local com posers. He is looking to play some Abenaki music, or songs based on Abenaki material, too. For his first concert, Feurzeig eyed Beethoven’s first piano sonata, Bach’s first published keyboard suite, and Scarlatti’s first and 251st piano sonatas.
Feurzeig wants to send a couple messages by doing this every-town tour, although he’s reluctant to turn the project into “heavy-handed propaganda.”
First, he wants to show support for commu nity events and the idea of live local performance, which has suffered during the COVID-19 pan demic. Second, he hopes to draw attention to “the unsustainability of long-distance touring,” which usually involves flying.
“What unsustainable means is, it’s impossible to keep doing that,” he said. “I just want to show that it’s entirely possible to tour and perform and have a performing culture without hopping on a plane and going all over the world.”
Feurzeig will be traveling from gig to gig in a solar-charged electric car to minimize his emissions.
The music professor emphasized the importance of taking actions like this in local communities.
“If I choose not to fly and I don't tell anybody about it, I'm just erasing a couple of flights here and there,” he said. “If I decide to tell people about it, it normalizes the idea. It's no longer this crazy, wacko thing. And maybe for somebody, the 10th, or the 20th person they hear saying, ‘Oh, you know, I've decided not to fly anymore,’ it no longer feels like an extreme choice to make.”
He added: “Just in my little world of music per formance, this is my small act of resistance against the jet-tour model.”
BAILEY BELTRAMO | EXTRA CREDIT Use the camera on your phone or tablet or visit go.uvm.edu/pianotour to learn more about the tour dates and locations.
Creating
FOR WELL OVER TWO HUNDR ED YEARS, the University of Vermont has provided students the opportunity to improve their lives, the lives of their families, and the lives of their communities.
We are deeply committed to maintaining this heritage by empowering excellent students from all backgrounds to pursue their passions and lead productive and consequential lives.
YOUR SUPPORT FOR SOAR:TheCampaignforStudentSuccessatUVM makes a UVM education more affordable, more vibrant, and more powerful.

Join us today—as UVM shapes tomorrow.

opportunities, for everyone. soar.uvmfoundation.org


UVM MAGAZINE 617 Main Street Burlington, VT 05405 NON-PROFIT ORG US POSTAGE PAID BURLINGTON VT 05401 PERMIT NO. 143 Vermont Catamounts had a year for the record books in 2021-22. Relive, or discover for the first time, how 13 of the 18 varsity teams contributed to the historic year. Pg. 28[ [

 SARA WHITE
SARA WHITE
 Photo by Glenn Russell
Photo by Glenn Russell

Joseph Russell ASSISTANT DEAN OF STUDENTS
Joseph Russell ASSISTANT DEAN OF STUDENTS



 By Abby L. Goode '08 Publisher: University of North Carolina Press
By Abby L. Goode '08 Publisher: University of North Carolina Press





 Story by Jeff Wakefield • Photography by Bailey Beltramo Additional reporting by Joshua Brown & Ian Thomas Jansen-Lonnquist
Story by Jeff Wakefield • Photography by Bailey Beltramo Additional reporting by Joshua Brown & Ian Thomas Jansen-Lonnquist




































































